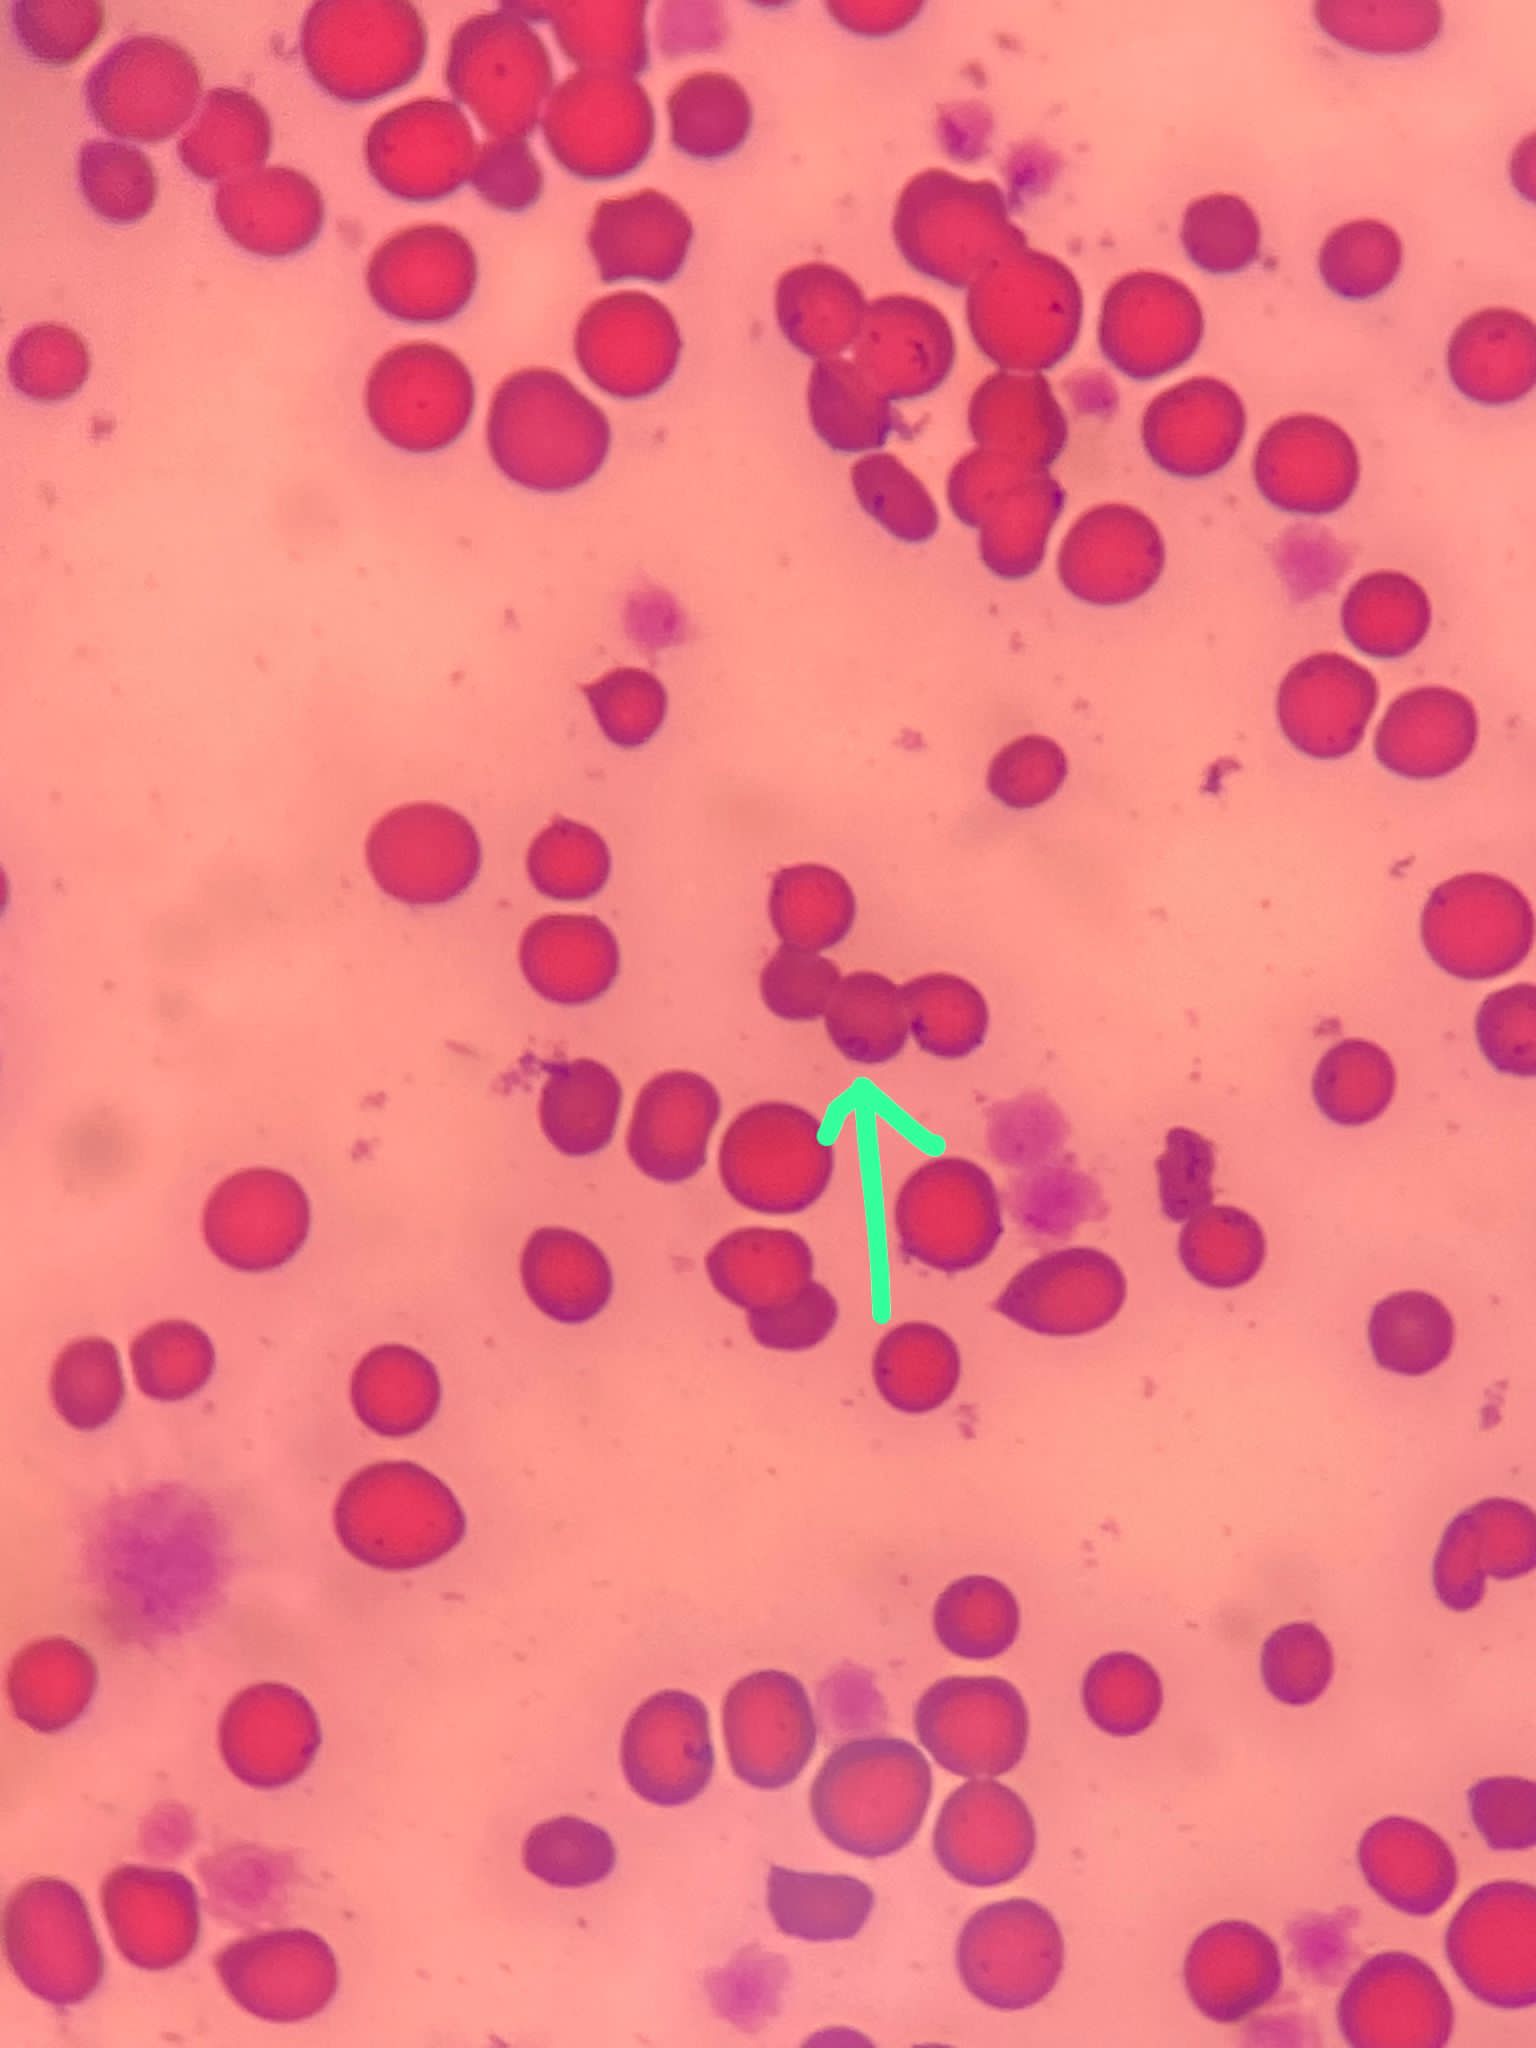

Off to the Rainbow Bridge
M, Neutered, no ear tipped
FIV + FELV – (April 2022)
Living with 4 felv+ cats cos staying w mama Kerry
6.18kg 17.1.22, 6kg 18.5, 6.19kg 10.8, 6.44kg 17.12, 5.92kg 19.3.23, 5.64kg 11.4, 5.28kg 25.6, 4.73kg 14.9, 5.05kg 21.9, 4.99kg 19.10
Latest darbepoetin: 5.10.2023
Ongoing meds: Subcut, azodyl, cystaid alt day
Health log updated on 29.10.23
Handsome boy, currently very terrified of Tao Tao and lost his fur. His mum, Kerry is victim too, please adopt the 2 of them together soon.
02 Mar 2025
he is back to 猫房, I put his urn temp outside to face mama. Kerry and daring drink water, eat will see him




27 Feb 2025
9.20am: I know im on stress mode when i sleep late. I had been waking up 5-6-7am for the past months. I scare to find don don dead. From Ip see daring only, can’t see anything else, and keep lagging I can’t trace at all
10.25am: don don is alive! I didn’t go in yet cos I need to prep med but he respond n he is breathing I didn’t see his face yet
11.38am: going in to prepare don don on sb and a mat to rest on.
12pm+ his nasal tube is out. Front paws dirty so I clean him up. Let him lie in the middle of room. Rest so I can see him from Ip. Sayang him. Syringe fed him 20ml of RC liquid. He can’t swallow. Scare he choke. His eyes still got hope, but body condition n the tube is off no food intake no hope le. How. Told him to leave if he need to. I told mmm the updates, unless I want to let him put ng tube again? (She say no no) If not sure is no more le. Don tube always off the next day, so use only once. Sigh. Sit down n brush all 3 of them. Pre rmpt mama and daring that don don is going. Mama know. Mama show off she is chubby n cheerful so don don feel safe. Daring – I fold daring to sayang don don say he is Kerry god son will help take care of Kerry.
2.03pm: didn’t move but i can’t confirm cos i trace back till 12+ I’m in he is same position. Resting.
6.50pm: Fr 4.52pm to 6.50pm no more movement. I trace to 4.52-4.53pm he looks like he did move a little at mouth area n gone le
Informed mmm and jo.
6.57pm: mmm“Looks like. No breathing”
9.29pm: jo”No breathing sign”
10.23pm: analysis of what to do w his funeral. Tmr my schedule is full, sigh. I don’t want to rush thru, so I’ll arrange cremation company come on sat. Tmr I’ll let don don hear the usual chanting rounds. No flowers cos he is in mummy room. Just how he is lying down tonight. Mama n daring will take care of him. Tmr we will have a sit down sayang round. I’ll think of what time to book for sat, 11.00am sound ok.
Don 28.2.25 Fri
Morning: prepare him, belly v round. Body structure looks fine. Can stay till Tmr. Mama didn’t confirm don is gone alr, I sayang him, prepare his wake, sayang Kerry n daring thru out, and Kerry head butt don tell him wake up?? Wa that scene I cry. this Sunday will give away one bin and their bowls.
5pm: mmm buy flowers for don don
Don 1.3.25 sat
10.55am: don left 猫房

























































26 Feb 2025
Morning: i syringe fed 6ml recovery he can’t swallow at all I know he can’t le. He is keen on cat grass but cannot intake anything. Today he is weak, he flop when he is on the oval sb and he is weak. I Subcut n gave him all the jabs needed. I know is the last try la, I bring him in for dr nally to put in a nasal tube. I bring mama Kerry along to accompany him. Mama keep stepping on him, I almost scare he die in the carrier cos too flat. dr put in a 6” size tube without any sedation, but she said don don alr twig so not looking good. Will draw blood to check calcium and glucose for now. and finish the stitching of the tube and I’ll bring him
N mama back. Will buy a bottle of recovery liquid if possible. cos need very liquid food.
2.76kg with fluid alr built up. Dr did mention that if i manage to tube feed any food into his stomach, but if his stomach is compressed by the mass, he also can’t make it. Noted. I know is the last last chance le. I bring mama to clinic w him so that anything they will be tgt till the end.
12.32pm: don tube is in, at 31/32 marking.
12.41pm: bg 3.9, calcium 9.6 – so his twitching is cos of kidney toxic. nothing else can be done. Will bring him back happy w mama n daring and see how.
1.20pm: the tube is really fine. Even the recovery liquid is not easy to feed, I Tube fed 40ml. He needs 42ml per meal, 130ml per day. He twitch thru out. Not looking ok. By logic I would have brought him home n to center. But Kerry can’t be tagging along, but I’m sure he rather be w his mum than me being logical. So I let him rest on a Peepad on the oval sb. Daring look after him.
1.52pm: he is sleeping on oval sb, I can’t see even the fur is moving, so can’t be sure is he even breathing?
4.45pm: he is at the cat box, can’t trace much till 3pm+ he is alr there
7.56pm: don is still in that box – alone











22 Feb 2025
Morning: I did feel that don fluid is building up alr. His bupre got to be daily.
He is keeping close to mama.
Night: mmm;”Came out of bin n stand in front of water bowl n cry”
Don 23.2.25 sun
11.14pm: mmm:”I didn’t see Don since I came back at 530”
Don 24.2.25 Mon
Morning; when I put in earthmade fresh plate and treats. He did come n smell more than 30 times and take 1-2 bites but the food just drop off fr his mouth, don’t think he intake any. This is not nauseous le, he can’t smell? Duno why m I thinking of doxy. I syringe fed him 40ml of aixia oldie and apply appetite stimulant other than usual Subcut n jabs.
He is resting in the oval sb. I told him this lifetime live very well as a good son/ cat. Told him next life his life sure will very good.
Don 25.2.25 Tue
Morning: didn’t look good. Syringe fed 10ml RC recovery – he didn’t swallow it. Sigh should I ask dr Nally how she will put in a nasal tube… sigh considering first








18 Feb 2025
Morning: given Clav jab
Night: mmm send me pic – don eating w mama


17 Feb 2025
9.15am:’mmm”Last night, Kerry came for pats. N she called Don to come for pats”










Told don don tell mama he going clinic see what else can be done. Drain some fluid or what then go home let her kiss kiss. Duno the below chin area is it internal mouth issue that spread down or cancer or, cos now is 4 holes, w 1 is the main access that I can push some Pus out to clean, I clean yesterday and today got more.
9.55am: see Dr d. She weigh don, 3.13kg same as yesterday. She say ya full of fluid, but I feel he didn’t look as bloat.
The chin part is abcess from the mouth (need dental which is impossible for his case), need ab – Clav. Later then ask should stop Marbo or not.
She bring don in to take bp and also u/s to see if the fluid is tap-able or not.
Dr d says she show dr ym aw u/s pic and she Duno what it is, meant be the shots r bad or what. They will do it at their end.
10.19am: dr d told me that don bp is 92 on 16.1 (then stop amlodipine) then at aw, they use petmap says is 202 on 3.2 (restart amlo) then today his bp is 80 only – have to stop that amlopidine (the diff between stopping n starting can’t be so great diff. dr d measure 8 times today. His bp is low n it’s in like w the pulse she took. They use Doppler Vet BP so more trustworthy)
10.33am: dr d show me an u/s says don don kidney r the worst she had ever see, full of cysts for both kidneys. She remember Raichu so this family has a bad gene of cysts issue pass down. Don fluid r ard the kidneys, not the same as norm cats who had fluid ard the intestine, she said dr ym says it’s the same as last time, so she is confident of tapping, will do it away fr the kidneys. But the tapping won’t stop the cyst from leaking again. (Dr d mention more them twice that cysts r painful) noted that the tapping is more benefial to don don, only damage is my pocket) and the coming back is next time biz (maybe monthly tapping see how first).
She wanna reassure me that they r doing the best possible measurement of bp, they measure don don hand is 2.7cm, using cuff size 2 or 3, using size 2 is bp 80, using size 3 is bp 90. So confirm low low. Stop amlodipine.
11.16am: the friendly nurse came out w don n his fluid drainage 450ml pale yellow, but not that colourless, now he is 2.73kg.
Just now Dr d mention he is very quiet n she sound like they will draw out without any sedation – and yap they didn’t cos he is super cooperative and still. dr d says 400ml fluid drain n there r still more, but it’s alr a lot. So didn’t take further risk.
ask Dr d summary of what should I continue from Today:
11.30am: bring in to take pcv (dr d miss out it’s 19% only on 3.2) and alb (this will not affect any decision making for tapping but as a guideline to keep track if he is worsening its going down. Last check 16.1 is 24, 23 n above is normal)
Sound like I have to book dr d next month appt it become a monthly event for don, i try to make it 1.5 month if possible?
Pcv 23, so buffer for the fact that pcv slightly highly than HCT so still ok even if it 20%.
Alb 28. So both safe for now.
Monitor weight I know but also not a good news it up (must be fluid built up) or down (lose weight).
Otw back he meow and look like a curious kid, looking outside, told him let’s treat each petspace visit as outing
Brought him back to 猫房 n he pee after I Subcut. Told him we will keep Subcut minimum.
Oh ya dr d says he had food in him – so he did eat
17 Feb 2025

15 Feb 2025
3pm+: he is dehydrated but skin like not that easy to poke. His mouth smell. I think Mon see dr d dr ym one more time to do what we can, drain his fluid etc I have to let him prepare le. his bottom check area got a pus smelll. Sigh.







12 Feb 2025
Morning: I top up fresh earthmade mackeral and he come out to smell but didn’t see him eat.
11.36am: still no reply from dr d
Night; jo photo he is in bin, but can’t see face at all.
11.29pm: still no news from dr d
Don 13.2.25 Thu
Morning: weigh him 3.32kg, very bloat, abdomen v bloat, thinks need to drain but Duno how much it will cost for each visit/drainage.
night: dr d confirm w me Mon slot alr. But I think I need to check aw ondansetron cost.
Don 14.2.25 Fri
Morning: Inform mama n don Monday I bringing don don go vet




11 Feb 2025
This coming Monday I plan to bring don don go try again. 8.19pm: still no news from Dr d. Today i mention about Pts to jo, in case he burst till I feel the need. But im still doing everything to save him but be realistic, I don’t know is he able to survive for next 1 yr.

09 Feb 2025
Morning: I know his body condition is getting back, the 2 holes below his chin. One hole zoo out pus today. Clean pus and blood away. N I touch his tummy both side extreme swollen. Fluid built up, should I start frusemide? Even minimum? I can’t trust dr n /b to do the draining but dr y is far too ex. Dr d in? But also same Ps tooooo ex. Or should I ask for her opinion to start low dose frusemide ? Cos of this, i told don don if one day he feel that he max up n need to leave us, go. I scare he hold on for mummy cos he is such a darling boy who love his mama to the core. But I also remind him as long as he isn’t that uncomfy, I’ll help him as long as he need
Don 11.2.25 Tue
Morning: he is as norm. didn’t see him eat but intake should be fine. But the abdomen is really big, scare he is in pain. Even jo see alr also sad, too much pain. We scare his cysts will burst. I texted dr d: “ Dr, you aren’t working this period right? Can I ask you Re this cat (he did know something about don since last visit w dr ym)
Think his fluid built up again. But also don’t know is it the cyst growing. I just feel that tapping is extreme dangerous. But w his kidney issue, should I even think of trying to try w low low dose of frusemide?
4.15pm: dr d :”Cyst? I can only see ascites mentioned in the chart from Yeumee. Furosemide doesn’t help much with ascites usually. Kidneys will not like furosemide. You need to do bp” – I send her the X-rays and bloodworks from 3.2.25.
“Is that kidney? Need ultrasound to check though” – Dr nally can’t be sure. She said might be, n if it is, then scary.so I don’t dare to let her do any tapping
“The weird thing is Yeumee wrote fluid around kidney, not normal also. So maybe last time it burst. Was checked for FIP….?” – Nope. But can’t be fip. Cos still alive till now
“Kidney cysts very very painful eh. How long already problem? Have I seen the cat?” – Should I bring in for u to tap? Or let him be? I think u see him for kidney b4
No fluid issue before. Till that date when he saw dr yeumee. First time.
“I need Yeumee around if we check before I dare try anything. I need ultrasound” – aiming to go on Thurs when both of them r ard, but 3pm slot I can’t make it. Sigh.
“Give bupre eh” – sigh Dr nally told me to stop. I had been giving alternate cat. So I’ll give back daily 0.04ml per kg, ie 0.13ml.
5.58pm: waiting for dr d to confirm that dr ym is ok on 17.2 Mon. I’ll inform Kerry n don Tmr.



04 Feb 2025
11Am+: restart him on amlopidine, Marbo (today I give last Clav as well), Cerenia n ondansetron. I got enough till next week. put him in the picnic cage to monitor that he can pee. Tmr once I confirm he did pee, will let him free roam again. Told mmm help put food for him at night.
5pm+: he is resting in the made shift letterbox
10.11pm: mmm haven’t serve him food
11.03pm: mmm:”Plate from inside. So hungry. Box is wet. Kerry tried to go in to be with Don. Don crying” btt she send me this she has bathe le, so can’t tell her help release don – Tmr then I let him out
He did eat the food that mmm serve and afternoon kakato he did eat half
Don 5.2.25 wed
9Am+: got pee, but didn’t look that regular, but still release him. Serve food he did eat immediately.
Don 7.2.25 Fri
Morning: serve kakato tuna w seaweed, he is first to come down to eat. Eat a little only. Better than nothing. Today is darbepoetin day, so lots of jabs.
Don 8.2.25 sat
Morning: the below chin area is a little scary. Still scab I try to clean up and he eat kelly n co freeze dried treats

















03 Feb 2025
10.30am: serve tuna w salmon, he got come out of litterbin n ate a little. There r 8 PCs of indoor vomit in the bin where he sit on
11.38am: seen dr nally. She did hear mur mur. 3.48kg – gain 220g in 3 days, gain fluid. Taken a quick u/s scan, his cysts are all surrounded by a big ball of fluid (scary as in not sure is it the kidney itself, if yes, means the kidney super swell) or ???! N yet there are still some (little) free fluid outside the ball. For both side. Rejected the tapping. Too dangerous, might just burst the kidney/ ball.
Taken Cbc and lytes only.
Kidney sure cui.
his HCT drop to 19%+, to continue weekly darbepoetin. Potassium 5, so no need to give kcl in fluid anymore. Dr Nally sound like she wanna me to give less than 100ml fluid. I’ll deem fit. Taken bp, 211/105, still high cos stop amlopidine since 16.1. She want me to restart it while continue semintra. Clav to stop and change to Marbo 2.75mg 0.45ml. Dr nally view/ she noted that I had stop these/ ranitidine, Cerenia and ondansetron. She said if anything she want to keep and will give since don will feel like shit cos of the horrible kidney will be ondansetron n Cerenia. So I got to restart that 2, didn’t top up ondansetron today. Will see how much my stock will last till. Today given Clav still. Tmr restart amlo, Cerenia ondan.
12.50pm; When we r back to 猫房, don eat Japanese pouch orange- he seem to like it
4.55pm: mmm:”Came home to see this.”










02 Feb 2025
Morning: today apply appetite stimulant for him.
9.49pm:mmm”Came out if bin. Don is eating” – video of don eating wet food. I did see him eat kibble normally, but just not that keen on wet food.




01 Feb 2025
12pm: I clean up his below chin today. Don’t see it’s getting serious but Monday let dr Nally see properly one more time.
I think I may restart ondansetron since I still have it.
I found a teeth in the kibble bowl, I did see him eat all 3 types of kibble, indoor, cou cou and earthmade. Not sure is it his teeth.
9.04pm: mmm”Clean bin n he’s inside since”





31 Jan 2025
Today I check on his under him, 2 holes. Clean up further. Today restart Clav, will bring him for checks on Monday. Teddy bear Tmr will go n take his slot.
3.26kg – gain 50g in 2 days


30 Jan 2025
Just a thought. Don looks dry. Most medi stop. Now left w bupre, semintra, Subcut daily. Darbepoetin, b12 b com weekly. Fercosang monthly. Ondansetron want to continue? Left some not sure.
Yesterday he is 3.21kg, gain 100g in 4 days.
Morning: told him I didn’t see him eat much. So I syringe fed 35ml aixia oldie. Today day 1 no Clav. But I found out his right below mouth area seem to have an abcess that burst. Not pus but got hole and got blood. Not sure is that original issue or new. I think he should just have another 7 days of Clav to be safe. Tmr restart.







28 Jan 2025
12pm+: given him a Ang bao. 压岁钱、told him stay healthy and cute baby. After Tmr I’ll stop his ranitidine. And Tmr is his last day of Clav jab. Today I also skip ondansetron. Cerenia alr stop last week. Getting less med. see how. Today drip is without kcl also. 1.2 review then see how is the status of Cbc n lytes.





25 Jan 2025
Mmm took video he got eat. Tmr I need to rush back but I think I’ll syringe feed him.

25 Jan 2025
3.11kg – drop 80g. I stop Cerenia today. Clav, bupre, ondansetron continue w Subcut n semintra n ranitidine


22 Jan 2025
Morning: 3.19kg gain weight. Have to change all dose of med again. today down ondansetron, he did eat, drink, pee and he sit in bin again. I did feel his body structure / skin better today.
Oh ya I forgot to log this on 20.1.25, ps: “uricult for Don is negative at 48 hours.“
Don 23.1.25 Thu
Morning: I throw in a toy for them. Don is interested. Today I told him I’m not feeding him he got to eat on his own ah.
Also told him I scare one day I can’t come back so frequent how. I can smuggle just him back to home but how to bring both him n mummy. Then daring will be alone. Sigh. Then kp also.
Don 24.1.25 Fri
Morning: I did see don go to plate to eat. I didn’t syringe feed day 02. Body structure n skin looks better.












21 Jan 2025
10am+: yesterdsy mmm alr told me he sitting in bin, still sitting in bin. Looks ok. I told him I bringing kp to vet then I come back
Today still give med as usual. Tmr I think I’ll try to half the dose of ondansetron. 0.39ml. Ondansetron not to give for long term, max 5 days? He alr more than that. I’ll stop soon. See first.
Cerenia I’ll from 25.1. See how. I arrange his Cbc review on 1 feb. his Clav should stop on 29.1 (14 days Clav)



19 Jan 2025
6.32am: mmm:”Seems all 3 uses the same bin for pee n poo. Other bin with box is for sleeping n sitting” – she send me video of don really drinking water, after drinking go pee. Yesterday his fluid is added w kcl.
10am+: i serve food and he did eat w Kerry and Daring. But he eat a bit n walk off alr. 12pm+: fluid v hard, cos keep poking thru his thin skin, sigh. Fluid is minimum.
Then I syringe fed him 40ml k/d.
Tmr need to remember to weigh him.



17 Jan 2025
7.57am: I’m worried that he is sitting in the litterbin. As long moving can le. 6am+ he is sitting outside. For now his routine will be daily I let him out to see his mama. Give ranitidine first. Then he can walk about for half hour then i give him food n med.
then back to cage for me to gauge if he sit.
11Am: by the time I enter his room cos lots of medi to prepare, it’s quite late that he didn’t get a share of meal just now. But yesterday overnight food he also didn’t eat. Lots (not sure is it) of poo, but it’s diarhhoea la cos pasty that’s all over the box and Peepads. will consider lactulose. Got pee also. So since pee n poo done, I let him free roam. I wipe his butt n back n hind legs w 10+ wet tissue, full of shit. No vomit.
Given 60ml of k/d blended, and semintra. Ranitidine given 25+ mins b4 tube feeding. Lots of jabs today cos restart weekly darbepoetin. I’ll aim for last slot b4 new year for review for don. He didn’t eat on his own.
Kerry looks happier to me today cos she see her don don maybe pass critical period since he can come back.
Mmm says yesterday night: “He looked so unhappy. N Kerry was frowning at me”
Night: jo send me videos – think don tube is out alr. Tmr need to cut it off. he got eat on his own.
11.44pm: mmm:”Don sitting in litter bin”




16 Jan 2025
6.20am: daring wanna jump onto the cat tree and land on don don cage and it flatten at the right corner, ok la. He still can stand.
11.00am: seen dr ym. Didn’t do any med b4 vet visit, he is last fed 11pm yest mainly for I know sure do Afast. N they thought I come in to put o tube only. Omg told her nope I’m clear in my msg n I wonder why keep insist me come even later which don’t make sense.
Dr ym say bladder not big, yap cos he pee le mah. Might be constipated then will enema here, or fluids build up swollen so round both sides.
3.26kg – wa gain 390g in 4 days. Not good news still might be fluid built up. Might need to drain, but if drain need sedation, then might as well put tube? Have to see how later on.
I had done all the tests, Cbc chem15 lytes, sdma, urine, upc, bp, Afast n potentially X-ray to see if he is constipated, to know how constipated.
11.46am: i know don is in room 2 waiting for dr ym to do the u/s scan.
Dr told me to go in to see her scan – both kidneys irregular in shape, like got holes like that (pic la, but he got multiple cysts on his kidneys) liver ok.
He got quite a bit of fluid ard his abdomen but not in the lung. So lung still ok, most prob all cos of heart. Dr mention about echo I brush off. She mention about mild sedation to tap some fluid out (ok) and since doing so, might as well put in a ng tube (b4 I come I don’t want n think maybe next week then do, then that moment i agree to do it n she agree n I think I feel not doing it; n ask maybe wait for next week, she say might as well now n the risk is low) – so do it. Just do it. I’m still scare.
12.41pm: I’m waiting outside the room for dr to drain fluid. N most prob will test it.
His Cbc anemic restart 22%, have to start darbepoetin once weekly again.
crea bun better w sdma 27 increase from 22. so is heart issue. Bp is low. Erm. So retry semintra and stop amlodipine. cos his proteinuire seem a bigger issue than bp now. b4 bloods r out, I’m seriously thinking of letting him on iv, now no need. Potassium 3.1 can add kcl to fluid le.
His alt is v low, cancer like to me.
So sum up for now: cut amlopidine, add semintra and Darbeo freq, kcl.
Buy more ondansetron, ranitidine, appetite stimulant. Continue Clav
1.02pm: they bring don in to put ng tube. Don
Is now 3kg means 260g fluid drain out, pale like his urine colour. Means kidney leakage ? But that’s extreme toxic so I don’t think so
1.34pm: dr ym says tube in, so he is safe le. Just sit in cage to hope that he poo out some hard poo b4 i bring him back.
with 3 way plug for the tube.
Semintra start 0.5mg/kg, so give 1.5mg (start Tmr la cos I can’t go into med room anymore)
2 enema in clinic n only one piece of poo out. He didn’t pee in clinic.
3.13pm: we reach 猫房. I dump all meds into fridge, given 27ml aixia oldie and some water into tube n he wanna vomit Liao loh. The 3 way tube they didn’t close it just now, like alr not v smooth. Given Subcut n given ondansetron and Clav. I skip bupre n Cerenia cos she said she give Cerenia just now and bupre i saw on bill.



15 Jan 2025
7am+: both paws also swollen, but not much more swollen than yesterday. Subcut v minimum w all the meds go in n i stop. Given 18ml ad using 1ml syringe maybe a little went in. His both stomach bloated. I think of Raichu, cysts? Kidney both swollen? Bladder very full? Can’t pee? all unknown. I set up a new picnic cage for him, he quite calm. To make sure he can pee.
I’m slightly happy when he Stand at the kibble bowl he did smell like he going to take a bite – earthmade mackeral but he didn’t. slowly hopefully.
Thru out the day, Kerry did go to the cage to see him. He can see mama. Tmr going to see dr for more treatment alr. N come to think of it, his fluid can’t absorb then my meds in fluid like Erm … should I just jab onto other part of his body without the fluid pocket?
10.03pm: mmm”Looks like Don is eating. I just peeped” – I checked like a bit wor. Can’t be sure. But did seem like got. I think got eat yeah got eat 🙂 Tmr Duno what to test. Think need to test fpli. Which I think have so no need to test cos I alr given pancreatitis treatment
11.00pm: i serve Kd – didn’t eat. I serve w earthmade mackeral, didn’t eat. I syringe fed him 40ml kd- successful he can swallow! So getting better. I think Tmr I can don’t do any tube. Will check status and see how. Or if tube placement is needed, shall do it next week.
He wanna go back to the cage himself. Subcut him w bupre n ondansetron. N he did pee. N body not wet, so is not leakage is pee. So now still kidney status and whether constipated or not.








14 Jan 2025
6am+: illusion? I thought he better by 3%.
Syringe fed 24ml aixia Oldie. I doubt anything went in, all foam out, don’t think he can swallow aka sure need o tube but I cannot imagine how I m going To Tell Kerry when i bring him back dead, then suddenly i think of nasal tube. Oh ya can hor. That’s a good choice. told both don n Kerry. I will go Ps on Thurs bah. Today reply can’t go aw alr inform them Yest night cos I need to be back mama home at 2.00pm. will see how ondansetron work till Thurs as well. I check his ears. Slight yellow only. V slight. So means all still good. Maybe mouth somewhere pain? Throat? If throat stuck alr dead. So Duno what’s wrong. Clav is helping bah w any inflammation.
I try to go back give him another night dose of ondansetron.
7.18am-10.27pm: he had been sitting at the water bowls area. Diff bowls.
11.17am: mmm”He was drinking. I opened door n he stopped” – but I think might just be dipped in water.
6-8pm: walk about a lot, meow meow meow. I think later I got to give him a bupre and ondansetron.
7.40pm. He got go find mama, can climb up the stair stool. Didn’t see him jump. But can move about. He did in out of bins a few times. Is he constipated? Tmr I got to stop nutriplus help. For NG tube I need to remind dr ym to put 3 way plug.
9.41pm: mmm”Didn’t move from there since I came back”
10.37pm: mmm:”Go pee also together?” – they r close tgt
10.45pm+: mama still come find me sayang. She know I didn’t give up on her son n don face itself look at me n he know I’m making all crazy effort to be back again n I’m not giving up on him. But found out his front right paw is swollen w fluid like timmy. Hopefully is cos of too much fluid this morning but it’s 6am till now. Erm. N yet I need to Subcut a little again, left side cos I need to make sure bupre n ondansetron is in.
12.40am; mmm”Just there. Not drinking”











13 Jan 2025
9Am+: still look bad in the lower box.
10am+: serve aixia oldie and gim apple w apple, not keen at all. He walk out of box and I carry him onto the hanging bed to feed. Will meow each time I put something into his mouth. Today syringe feed day 3 bad. Getting worse. He can’t swallow at all. I stop at 18ml. Day 2 doxy don’t think anything go in. I feel the med oral non go in.
10.27am: Clinic phone reply me 10.30am
N I on them. Cos don need to do a through check n I know dr ym will check a lot. And I want to play safe let her feel it’s safe n need to go thru that O Tube. N I just pre empt the phone that don most prob need to put an o tube in, I didn’t say I bring this cat in for o tube only. who knows …
1.50pm: they change my timing to 1100am – don’t make sense when I ask for early timing n yet now if need do o tube they give me later timing? And attitude threaten me if not they just release the slot. Damn kns. Tolerate that msg for don. Irritated.
2.07pm: alr send clinic info enough to register, and I did mentioned I had sent details to dr ym.
Dr ym didn’t read n reply now (4.03pm).
3pm+ :Send in request for 2 meds that I want to start don tonight. Asap. (Aw can’t dispense, n I can’t wait till Thur) paid n i arranging to collect.
3.27pm: Ps send Thurs cannot do don o tube since i don’t want them to contact aw for record. But nonsense. for what siak? I know dr ym will do the latest most updated bloods and u/s n etc so for what? Damn bo Liao. Damn irritated by them.
Anyway slot in 2 things, one is convo w dr d:
12.13pm: dr d:”Need to see blood test. Ultrasound kidney done? Most likely had ureter stone also”
“UPC done? I would trial ondansetron with mirtazapine first. Another GA might not be great for heart and kidney”- I told her the rational of mine that I know the risk n yet can still have that thought.
“No meds for proteinuria? He is actually diluting, very very low usg. Ultrasound kidney need to be done also” – told her about don anemic reaction to semintra.
“Then ace inh for proteinuria possibly, but if he keeps loosing this much protein, kidney get worse. I would retry semintra low dose but yah, is risky. Blood pressure was high?”
“if BP still high, can also up amlo to reduce bp”
“GA will be extreme high risk in this state” – cos he can’t swallow when I syringe feed him?
“have to be full GA. otherwise choke”
Re ask dr d re the fact that ga is too high risk for now, But cannot get any medi into him other than the jabs,
What would u do? – “ondansetron injection, maropitant transdermal, mirtazapine transdermal, and i would start with antibiotics in case pyelonefritis. if then still not eating, no choice but super high risk” – she dispense for me 3 days supply. So means 2 days must see positive effect.
“doxy can cause problems with swallowing . if eating, i can dispense more. but its not cheap. so no use buying if not working’”
Ondansetron 2mg/ml – per amp
0.71 ml, its 0.1-0.5 mg/kg, start with high dose, if effective can try lower (the official dose is 0.1-1 mg/kg but ive never had to give that high)
I’ll do 0.71ml x 2 for 2 days and see how for third day.
And
1-2pm: from Ip: don sitting in bin. Scary
3.25pm: fr Ip: don Walk from water bowl to cat tree and can’t see cos cut off, but he seem to have a short episode of seizure. Sigh. Think Tmr gonna see vet alr. I need the latest info. Sigh. V sianz of Ps phone attitude. If vibes wrong all wrong.
4.30pm: can’t see don in any of the cams
4.41pm: fr Ip: he is sitting at the water bowl. Think he can’t drink? Something not well? He sit there for 20-30 mins type. Tonight must give Clav.
6pm: so late then got the med. later go back targeted these and Clav 0.29
6.44pm: dr ym saw my msg now or she just reply now. She wanna slot me for Tmr 930am but I can’t la. “Otherwise can drop off tonight for tmr? If stable to sit overnight in cage”. – this is hell no. It’s hell for don. He will depress overnight. No way I going to expose him to such torture. I wanna let him see a vet properly then decide to do o tube or not. I m v sianz. Sigh. SIGH.
9pm+: rushed back. Don look ok. Just a little sleepy. Told him and tell mama I didn’t give up on him, maybe just not going to put o tube anymore, we try what dr d says. I need to Subcut him a little cos I scare the med will poke thru. Subcut n fluid come out. So ondansetron n Clav 0.145ml given.





12 Jan 2025
Morning: hiding. Don’t look ok. I look in, didn’t see any vomit. At least food kept in
Today I syringe fed 30ml ad only, not sure half in or not, cos he isn’t swallowing. Only swallow twice n I call him good boy. But I think he can’t swallow, don’t know v uncomfy or mouth throat pain? I think taking a risk to put o tube now is good, right b4 new year safer.
2.20pm-3.09pm; drink water and still sitting at the water bowl area
Dr d not working in Jan anymore, trying to ask dr ym can have Thur earlier slot for don, I want to do a check and put in a o tube for him.
9.26pm: mmm”Went to get love from mommy”










11 Jan 2025
Noon: I’m back to 猫房 after snowy cremation. He looks cui. In the lower box again. Don’t like the feel. First day try to pump him w food. Today tried 1/3 can of Ad. Too much. I scare he vomit. Eventually given 40ml. Still ok did swalllow but not all. Ok w nutriplus. Meds foam out. Subcut n jabs as usual. I scare he vomit food out but Cerenia is covered.
Night: photo show he isn’t alert yet.


07 Jan 2025
9.22pm: mmm”so skinny”
Don 8.1.25 wed
11am+: just feel that he is very light. Didn’t see him eat at all. I even thought of bringing him to put in an o tube. Will he pass? Sigh not sure.

07 Jan 2025
Morning: he is Hiding in the lowest box. When I serve food, kakato tuna w seaweed. K/d and aixia oldie he did eat some. Same as yesterday he did eat k/d – happy le. Better than nothing. He did felt lighter today. Today his medi is scary, amlodipine, omeprazole, phos bind, darbepoetin, fercosang, b12, b com, bupre and Cerenia.



04 Jan 2025
Past 2 days his right eye start to have that type of discharge. Pain? Need ab? Alr on higher bupre. Should I up again? or start some ab?

02 Jan 2025
Morning: looks v dry. Sigh. Sayang n hug him, still will play w catnip let him happy. Today vomit after oral med, apply Cerenia cream again.






31 Dec 2024

31 Dec 2024
Morning: 3.32kg – drop 40g in 11 days. He know I’m worried about him. He knows he got me, got mama Kerry and god bro daring.



28 Dec 2024
9.24pm: mmm”Don doesn’t eat”. – he know he is buying days alr. I got carry him to sayang him, he knows Subcut is the way. Alr put him on Cerenia and bupre. What else can I give? I can’t think of any. Sigh. Or I up bupre dose?

26 Dec 2024
Just logging their status look


24 Dec 2024
9am: he did eat
12pm+: Today I start don don on long term bupre 0.11ml.
Don 25.12.25 wed
7am+: serve breakfast he eat! Yesterday first dose of bupre so I shall continue


20 Dec 2024
3.36kg – lose 190g in 8 days again. Alr added on new med: omeprazole and Cerenia. Weight further drop sigh. I feel that I need to add bupre.

19 Dec 2024

18 Dec 2024

17 Dec 2024




13 Dec 2024
Today i started him on omeprazole liquid – seem disgusting. He is just a too good boy. given Cerenia also. Hope he feels better
Don 14.12.24 sat
He likes to eat the raw treats. Today he eat yum yum the treats only. Erm




12 Dec 2024
1140am: see dr Brandon
3.55kg – lose 1kg + fr clinic last record
Mouth didn’t look that bad, but right upper got some tar tar n gingivitises for sure
Faint heart mur mur
Dr Brandon feel his bladder quite big, can do a blind cysto – drawn urine easily 3ml.
he is a good boy, didn’t move when dr b draw blood from jacular. But blood didn’t flow out. Poke 2 more times a little blood come out but he move le. Hind legs also no bloods come out, poke 7 times today. So poor thing I hold him n blood slowly flow out. Looks thick not anemic for sure.
HCT 39% – I’m changing to once per month.
His kidney really cui Liao. Crea 8+, bun 11+, phos also high. Sdma sky high also I did sdma cos of his weight loss.
Dr told me add on Cerenia I’ll do that fr Tmr onwards. He didn’t take bp, sigh, don’t know can stop amlo or not. I’m going to restart daily. sigh. Fr dr tone, don don is ending soon. My fault? I always say he got to leave earlier than mama cos he mummy boy. But mama so healthy, you should last much much longer mah… dr say may have to start benazapril for his proteiurine, but kidney will cui die more. I rather let him take semintra bah. – both also cannot, will cause the bun crea to haywire. Dr b says rather don’t treat. So he think of way to make don feel better feel happier – add on Cerenia and omeprazole for him










07 Dec 2024
Morning: brought Simba to vet so don can’t le cos dr Brandon need to do surgery. All to do on Monday. Sayang don don, told him today give fercosang b12 b com.
05 Dec 2024
Morning: 3.50kg – lose 630g in 24 days. Really Duno what else to do. Sigh going to vet this Monday for the sake of going only. His face is so sunk in. I told him I feel that he got felv le, nvm he w mama will do. He is Kerry proud boy.




23 Nov 2024
8am+: don definitely much more spiny now – without weighing also know thinner. Other than i want to bring him go clinic to check status only, I know go vet also no use one. Most prob kidney. He still eat. But v little. Maybe I can add appetite stimulant to make him eat a lot?
Don 26.11.24 tues
Morning: he really like to eat the raw diet chicken treats
Don 29.11.24 Fri
Morning: deworm him w 1 tablet of drontal


22 Nov 2024





11 Nov 2024
4.13kg – 6 days drop 200g? Erm. Or the other time measure wrongly? Dose for darbepoetin remain 0.04ml.
Don 12.11.24 tues
7pm+: then I get to go into their room cos today grooming day. I’m dead tired. Given Subcut and meds n darbepoetin b12 b com today. One of these days going to bring him for review




05 Nov 2024
Noon: I’m back w sena from vet then do medi round. Yesterday he vomitted, today i Subcut w Cerenia also. 4.33kg-gain 200g in 25 days
Don 7.11.24 Thur
6pm+: today fercosang delivered so given him that w Subcut. I serve snack he and mama eat tgt



28 Oct 2024
Day: serve freeze dried treats salmon n chicken they both like n don keep waiting for daring to eat but daring keep eating non stop and when he drop one pc, don go near to want to take that piece n daring slap his face n don still want to eat


25 Oct 2024
9pm+: started ecoco coconut oil 1ml, he is always a good boy he know I don’t harm him





17 Oct 2024
Don is a good don, groom mama. I did tell Don I may skip today. V uncomfy.




15 Oct 2024
today darbepoetin day, given Subcut and b12 bcom




11 Oct 2024
11Am+: 4.13kg – lose 250g in 39 days. Think he needs to review for status le. But other than status, what will change? I think none. Sigh. His kidney alr cui than Timmy, Timmy is gone. I worried about don. But don b4 Kerry, kerry can still survive. Daring had been a nice bro always sayang don. Today given him Subcut, and given Cerenia as well cos past 1 week or so he had vomit thrice (last time he take in amlodipine he won’t have drooling one now will)






06 Oct 2024
12pm+: taken his bp, keep moving. Only 3 extreme reading: 114/94, 185/124, 232/202.
He looks so slim down. Still v close to mama

01 Oct 2024





26 Sep 2024




23 Sep 2024
Definitely dry and not well, but is the kidney, but he alr daily Subcut. Can’t up fluid anymore. What else can be done? adjust semintra? But he isn’t on semintra. he is on amlo that’s worse for his kidney, should I skip amlo? I bought a bp machine for him le. Waiting for it to arrive
Don 24.9.24 tues
2pm+: sayang him while Subcut him daily. He is a good boy. He tolerate all well cos of his mum. did tell him I need to bring him for a check sometime soon, to adjust medi
Given darbepoetin, b12 b com fercosang etc today






21 Sep 2024

18 Sep 2024


16 Sep 2024
Don suppose to have darbo jab fortonightly (Tmr) I decide to stretch 3 weeks so next jab I will give on 24.9







13 Sep 2024












05 Sep 2024


30 Aug 2024
Day: today too rush. Didn’t Subcut him cos he is high up there also.
Don 2.9.24 Mon
4.38kg – gain 220g in 2.5 mths
Don 3.9.24 Tue
Morning: I saw mummy beat up Don, don turn ard want to fight mode but see is own mama so he tone down. N the “fight” ended.
1pm: he is up there so today skip medi. Tmr will give darbepoetin.





24 Aug 2024


21 Aug 2024



15 Aug 2024





14 Aug 2024




10 Aug 2024
1pm+: i took his weight then I Subcut (4.6kg+) then I forgot his weight. But sure lose weight by 100-200g.
Don 11.8.24 sun
7am+: still easily sponked and run n hiss n turn fierce but I trust him not to hurt me so still ok


09 Aug 2024
1pm+: their room added a new toy sb. Don they all got sit on it.
Thru out the night don and mama got go eat and drink.
Daring now always sayang when I Subcut don.
Tonight jo photo show don quite dry leh. Daily Subcut le. Still so dry. have to weigh him soon




04 Aug 2024
Noon: sayang all 3 of them daily when I’m subcutting don, and all med done including darbepoetin and fercosang today


01 Aug 2024


30 Jul 2024


29 Jul 2024



23 Jul 2024
Morning: jo send me video that don is calling. Bladder issue? Calling for Xiami? Alley? Room too empty? I’m going to throw their bins somemore. Left 3 cats only.
Don 25.7.24 Thu
8am+: lose muscle le
20 Jul 2024

19 Jul 2024




18 Jul 2024




17 Jul 2024
Mmm send me their photo in the bin sleeping together/ don making himself comfy w mama beside him. Bin Become bed. Maybe can put a bed inside. But once Xiami is in, bed will be wet. Not sure how maybe try once



14 Jul 2024
Night; mmm”Can see Don lost weight”. – haven’t weigh but I thought seem ok






09 Jul 2024
Night: cystaid delivery. Need to start him on it again. Play safe
Don 10.7.24 wed
Morning: started cystaid. Will give alternate day



03 Jul 2024
6am+: fr ip he is eating kibble
Generally he looks fine. Today I given darbepoetin, b12 b com fercosang.
Still mummy boy



28 Jun 2024
11.35am+: come down to eat
Don 29.6.24 sat
Night: mmm”Kerry will call don to come n eat”




23 Jun 2024
930am+; saw him come down to eat.
Night: on the floor 🙂


22 Jun 2024
still close to mama. B4 I serve food to his room, I saw him eating yesterday food sigh
21 Jun 2024


20 Jun 2024
10am: start up there didn’t come down eat. Next time I should not serve his, when i go in then serve his food

19 Jun 2024
11.20am: see dr Nally. 4.6kg – Drop further 150g in 1 week. She press kidney he meow. Not
Bladder. To take Cbc but I ask to take renal profile also la (since 5 months Liao, see status)
But she say she hear a tint of heart mur mur – so I test pro bnp too – they borrow from hillside so later then can know results
When blood drawn I know he not anemic le, cos blood v dark red, HCT 35.6%, retic high, dr says can stop darbepoetin but I think can’t stop, will give 2 weeks later then monthly then stop.
Crea 6.4, she sat next step is Iv this i kiv first. This period can’t. phos 9.4 have to continue.
Have to up fluid amount by giving x2.
4pm+: aw”Hi Cat, will need to be cautious with fluid rates for Don as abnormal BNP, this can be related to hypertension so consider echo scan of the heart.” – 1 July then i give darbo again.
10.56pm: status: check ip on Xiami 6-10pm: didn’t see him come down at all to eat and drink (lucky 5.32pm he did come down to drink) but food how?











12 Jun 2024
Morning: i medi him and Subcut him and cut all his nails. 4.75kg – drop 200g in 18 days.
11 Jun 2024
12pm: i kns forgot to give Don darbepoetin dose on sat, miss by 3 days. Last jab alr. I have to go clinic top up, just give next Monday. or Mon I got to go clinic buy.


08 Jun 2024
1pm: Subcut n med.

03 Jun 2024




01 Jun 2024




30 May 2024
Alley passed away and I’m worried about don. Lucky mama quite Zai, she ard and don follow mummy ard so less stress also









28 May 2024
7.11Am: fr Ip, don is meowing. I can’t continue watching cos it’s loud. Duno he scare or like last time, block? Cos that day his bladder is alr full.
8am+: think he is hungry. Didn’t meow. Just stick to mama as usual. My Subcut as usual.




26 May 2024
7.01am: worried about alley so I check ip, don on the floor le
9Am+: kerry come out happily at door when I serve basic round of food, don come when he heard mama
10.45am: got eat, i throw the top deck one got eat also, means yesterdsy he did eat



25 May 2024
4.95kg – gain 10g in 2.5 months. Dr Nally record is gain 700g fr Jan.
Heart lung sound good
Bladder quite big – just have to monitor be careful (alr on cystophan)
To take Cbc to check on status – dr feel he looks fine based on physical examination
easy to take from neck, shave off some fur
HCT 18.1%. Wa have to restart darbepoetin 1ug/kg. Once a week. later go back count dose.
Back to 4G, given Subcut, amlodipine, phos bund, fercosang, b12 b com, darbepoetin.
505pm; going to move house to 5GM.
5.30pm: Reach 5Gm, don keep meowing – wa w mummy also scare ah
He is at the top house when I return w Xiami and daring







24 May 2024





23 May 2024
Still drink water frequently

22 May 2024



04 May 2024
8pm+: i change water bowls. He and Xiami still drink lots of water after I Subcut both of them 150ml each.
9.50pm; Duno why daring and don almost fight. Sigh.
23 Apr 2024
Night: Subcut and given fercosang jab and cypophan and azodyl, amlodipine and phos binder given
Don 29.4.24 Mon
8am+: informed him mei mei Raichu pass away. Told him eat. Eat as usual. Mei mei love to eat.
Don 30.4.24 Tue
Morning; today electric work at 5GM, getting ready their new home for them. Yesterday skip medi round. He definitely kidney still got issue but he is good w med. he wanna be w Kerry mama long2.




21 Apr 2024



14 Apr 2024
Night: v Zai w Subcut le. Clean his ears today. Right ear v dirty. Left alr dirty. But right very.
Don 18.4.24 Thur
Sorting out the cats’ microchip status. Scanned. Don confirm have.










08 Apr 2024

05 Apr 2024
10pm: I carry and hug him n sayang him kiss him happy bday




04 Apr 2024
Night: celebrate Kerry bday w don don tgt. 8 years le …. Wa. Kerry keep moving about can’t even take decent bday photos. Don got the stunned look as usual, I didn’t Subcut him today. Tmr bday got to Subcut. daring got really jealous cos pple bday? And he end up go quarrel w don








31 Mar 2024
Morning: after I sayang wawa, I merge all the usual 5 tgt. They r happy. Alley happy to come out and stretch more. Daring happy to see me. Xiami happy n is his cute little self looking at me to serve food.k Kerry mama I wipe her nose and don don look at me he look blur blur. Also serve weruva bff tuna w turkey, alley and don likes it. Later I got to feed them as soon as i cans today must restart meds.
28 Mar 2024
6-7am: fed them each 1.5 cans of food. Subcut him and remind them Guai Guai. No scare. Ah mao won’t be in for next few days so he no Subcut for a few days. Kerry mama like know something. Sayang her a bit only cos I need to Subcut don










27 Mar 2024
Just a status update: I think I miss out many doses of his darbepoetin since xiao Lian passing. Sigh. I think can try to wean him off then. will monitor and see how. I’m off this Thur. N now he is staying w mama in room b. Da Jiejie will settle their meals.
26 Mar 2024
Morning: Got helpers in to brush fur, clean ears and cut nails – he run of cos. Third time then done. Powu even sing song to him.




22 Mar 2024


08 Mar 2024
Morning: steam bath him w coconut shampoo. Subcut him, given b12, b com, fercosang. Aiya forgot to give darbepoetin yesterday. So Tmr then give.
Don 12.3.24 tues
11Am+: 4.94kg gain 120g in 7 weeks
Subcut almost daily n given amlopidine n phos bind n cystaid n azodyl


02 Mar 2024






20 Feb 2024
Night+: like cat grass a lot



15 Feb 2024
He likes kelly n co raw treats






09 Feb 2024




31 Jan 2024
4am+: just preparing meds. Today is day 14 of his Marbo jab then will stop. Will arrange review not so soon







24 Jan 2024
Today put on new year collar. Posing.
Don 25.1.24 Thur
While I’m in clinic w sweeties dr nally update that don don’t have that bacteria. So his cause of anemic back to unknown















23 Jan 2024







20 Jan 2024

20 Jan 2024
1040am; first to bath. Deshed some fur. will meow. groom and shower w coconut oil.






















18 Jan 2024
11Am+: seen dr nally for review
Taken bloods for Cbc cos I need to check his rbc. HCT 17.0% though gum looks ok.
4.82kg – lose some grams in dr record, mine is gain 20g
Change ab stop doxy give 0.13ml Marbo.
Check upcr also to see the effect of him stopping semintra. but I think dr nally forgot he start amlodipine siak – reminded and his upcr drip further to 0.23 from 0.42, so amlopidine working on him. Continue.
Done blood smear (Alex do one) – (Suspected blood parasite Cytauxzoon) – so send out for idexx blood film evaluation
120pm, back to 猫房 he go in find mama and I continue w sweeties stuff.
Subcut him w b12 b com darbepoetin Marbo. given all oral med. he will meow when he is thirsty n want water bowl
















15 Jan 2024

13 Jan 2024
210pm: he vomit out all the oral med just now
Look at him, staying near mama, look fine
9pm+: looks fine. he like hanging bed also. They understand movement restricted cos of sweeties is sick.

12 Jan 2024
He seem fine. But clotting of blood not that good. Given darbepoetin combo today. Next Thur review confirm.

05 Jan 2024
8am: didn’t see him eat.
Don 6.1.24 sat
Morning: Subcut him. and given meds. Night will Subcut him again. He is on twice a day now.
Don 7.1.24 sun
1pm; back and given him Subcut only. Give selar he got eat
04 Jan 2024
11Am: see dr nally 4.8kg I think – she say lose 200g. told her about the calling but can’t be confirm is him or alley. Dr didn’t say his bladder big n he didn’t show discomfit when press on. So not his bladder issue. So just review review.
Taken bloods for Cbc, phos crea bun sdma and upcr.
His bp is still high leh. But dr Nally didn’t say anything leh 184/114.
Sigh no hope to stop semintra Liao loh. Sigh ask again.
Wa his urine no more protein.
HCT 19.1%, wbc high. Sure need to restarts all the anemic treatment and give Marbo. His kidney cui Liao sdma 15, crea 6.3, bun 73, phos 7.8 also need start phos hind. Subcut alr a lot. How to improve kidney? Sigh.
I add on idexx fiv felv test cos his Cbc haywire.
Let’s see what vet says:
Don still fiv + felv -.
“Plan for Don:
– Restart darbepoeitin 1ug/kg/week
– Stop Semintra
Blood smear: true low RBCs, adequate platelets, just detected suspected blood parasite Cytauxzoan” – need ab?
Plan for Don:
– Restart darbepoeitin 1ug/kg/week
– Stop Semintra
– Add on doxy 10mg/kg 1x daily for now
– Recheck CBC/blood smear in 3days, tentatively cannot be certain is Cytauxzoon or if it’s another blood parasite, if blood smear still see same parasite, kiv submit to IDEXX for blood film evaluation (need 1ml blood)
– Continue BID 100mls HM SC fluids + start alumonium hydroxide 2x daily
Back to 猫房 w don, I got to go out alr. Told don sweeties Subcut more urgent. So tonight then I do his. Serve RC renal pouch he got eat he eat mama’s share.
“Don previously responded to marbofloxacin but marbo not useful against blood parasite.
DDX anaemia: Anaemia of CKD vs infectious blood parasires vs adverse drug reaction to Semintra”
summary of my treatment plan for don:
Night: doxy split is not successful so next tube I’ll give 2 notches.
Given Subcut, b12, darbo, fercosang, doxy, amp. He got eat w mama. Got clotting problem? He did bleed fr the needle












02 Jan 2024
Status: Think don don got problem. Better check whether he potential block again or not? Omg. Can’t get any slot today n Tmr alr. Booked for Thurs 10am.
9.37pm: just a thought – I feel like cancelling the appt. See first
Don 3.1.24 wed
5pm: snack round he got eat. N just now I heard is alley is the one calling. Mouth pain. So may not be don. Erm I really feel like cancelling the appt. See first – I think I should go 5G.
Night: review my record cos I prefer not to go vet (money, time, cat’s comfort and staying at home can monitor sweeties who is critical more) – but cannot. Cos don on semintra, I better retest his Cbc kidney profile and UPCR. So have to go. N urine analysis
01 Jan 2024
5+pm: v weird he meow his tail puff up Like fighting fiercely. I don’t think he fight w anyone. I even thought he fierce Mama. And alley is scared. Oh no he got problem again?
01 Jan 2024
7am+: status: Kerry and don sleep tgt in room c at night. Food intake has been ok.






26 Dec 2023

25 Dec 2023
Morning; jumbo like don and Kerry. Cos they cautious but didn’t treat him badly. He even groom don don. I have to wipe don face n head just in case, don’t want to expose him to another trace of felv.

22 Dec 2023
8am+: looks fine.

18 Dec 2023










14 Dec 2023
Night: worried. Cos he meow omg. Erm ermmmm


10 Dec 2023


01 Dec 2023
Dinner serve w Kelly n co freeze dried tuna w yellowish – he love
25 Nov 2023
5.02kg – lose 70g in 23 days.
20 Nov 2023
Night: ear so fast so dirty alr. Only one week or a few days after grooming? Given Subcut n fercosang and I’ll stop it for next month onwards

14 Nov 2023
3-630pm: grooming, ears very dirty and cut nails only. give him ciao cup as teabreak.





13 Nov 2023
Morning: this room damn smelly. Duno is who. Got one set of mashed poo. Cleared and the room still stink badly. later see how. Sigh.
09 Nov 2023



02 Nov 2023
3pm: see dr nally review
5.09pm: gain 100g in 14 days
Taken blood from jacular for Cbc, rena profile including lytes
HCT back to 49.5%, lytes ok. I can stop darbepoetin.
crea 4.7, bun 63 all worsen. Have to give more frequent subcut.
To take UA also. She wanna see got crystals or not. see how.
Urine v dilute like water – sg 1.007.
got protein n bloods. Taken upcr. Sigh upc 1.24 v bad need to start semintra no nego. 5mg once daily. review in 1 month. Earlier for the rbc
Night: started him on semintra.








01 Nov 2023






28 Oct 2023
Day 23 after I last give darbepoetin. I think I shall go for a check up b4 I decide he needs to be on it or not so me alr 25 days without.


24 Oct 2023

19 Oct 2023
4.99kg – lose 60g in 28 days. Got eat leh. Continue Subcut and w cystaid and azodyl.

18 Oct 2023
Night: serve tuna w white fish w nutripe mackeral w green tripe, v good biz, everyone like. Don like so much till he start eating from mama plate b4 I serve his


13 Oct 2023

06 Oct 2023
Summary: don alr stop Clav for sometime, today is day 16 he is on Marbo. Tmr onwards will stop too. So no more ab. I’ll continue fluid for now. alr stop the one w kcl also cos he eat plus I didn’t retake lytes these few days. Bupre and gaba continue for now. I’ll continue cystaid n azodyl. see how first.
Don 7.10.23 sat
Night; told him today no more Marbo. Given him bupre n told him can’t be a drug addict la. Tmr onwards we will stop bupre. He got scared cos jumbo attack daring, and kerry mama even want to go save daring cos jumbo extreme aggressive. Wa kerry really treat daring as god son.
Don 10.10.23 tue
Night. Now I go alternate for his Subcut. I stop bupre also. I give 45mg gaba. I skip cystaid and giving him that alternate day also. Only
Give him azodyl daily.


05 Oct 2023
Don eating more normal. always tell him char char mei mei tell u cystaid good, ah mao tell him azodyl good both swallow well.
I can’t be confirmed whether I remember to give him darbepoetin last Thurs, but given 0.06ml (40ug) today. B12 Bcom. Subcut. Azo. Cys. Gaba. Bupre.

03 Oct 2023
2+pm: first to groom. Water v dirty as expected cos of the urine cath mah. good boy as usual. didn’t make any noise in the bathroom at all. Ears dirty. Got some dandruff
Don 4.10.23 wed
Morning: just a thought, have to cut expenses further. And I shouldn’t go for review based on protocol, I don’t think I need don review. He appear better now and if I wanna check his kidneys, should at least wait for one bottle of azodyl finish. ThAt ard 1 month plus later.
This morning he is sleeping on the hanging bed – serve tuna w crab meat, got eat




























01 Oct 2023
Early Morning: so really in pain? Cos yesterday night give him bupre n he didn’t howl. Yesterday did eat quite ok
This morning give him gaba and cystaid and azodyl first.
Night: eating quite ok





28 Sep 2023
Night: at least looks progressing better though not ok yet, but i skipping Tmr vet visit. I m dying. Tmr another full day lessons. I should go back to see the 5G cats b4 work. That’s more impt than don reviewing for the sake of reviewing.
Don 29.9.23 Fri
Whole day did meow quote frequent leh. No choice night I re give gaba but he vomit out azodyl w it with bile. Sigh. Have to give bupre Tmr again see how
Don 30.9.23 sat
Meowing overnight and thru the day and even night time when I’m back. given both gabapentin and Buprenophine 0.15ml. See how. Didn’t look unwell but yet keep meowing.
From yesterday I had stopped his Clav, Marbo continued

27 Sep 2023
1pm+: Subcut him w everything except bupre. Given gaba. But he still meow. Erm. Still in pain? This Fri must bring him review see how the bladder now.
Night; happy posing w mama. Open tuna w ham w Kd stew didn’t eat at all. given meds. Sigh think will still skip gAba. Must be gaba taste awful. Tmr need to remember to give darbepoetin second dose





23 Sep 2023
Since Tuesday, so today is day 05 don didn’t eat. Or minimum as in not even 5%? Today morning I syringe feed him 45ml ad. Means Tmr morning I got to syringe feed again. He did smell and not keen. I even add on phos bind, probiotics and nutriplus help for him. Erm. A lot of medi alr. He is still loving w mama.
Don 24.9.23 sun
Evening: day n now also don’t eat, but looks good w mummy. He just a happy boy w mama. Still on twice a day Subcut. Have to review soon then due to in appetite.
Night; still not eating. But wa burp clam he got react, got eat one bite full one
Don 25.9.23 Mon
Morning he is still he, not eating.
Night: I’m back and can see he more active like that. I serve food mama eat and he eat!
Tuna w salmon 🙂 azodyl working or?
Don 26.9.23 Tue
Morning: got eat chicken ham w mama 🙂
3pm+: Subcut him n med.
and after that first time in his lifetime I feel scare. The aggression feel. Don hiss and wa the feel is scary. I feel he will jump n attack type. Very scary. I told him I’m scare he still got the scary eye. I told mama too. I bring mama to him hopefully Can calm him down but she walk away n I’m scare. I think I only stop his bupre one day, don’t think is painkiller issue. But I still give him 50mg gaba play safe. Try to sayang him but I damn scare. I can’t afford for my hand to be further Injuried. What happen siak. He learn fr jumbo? Sigh. He is always the boy I praise to others that no aggression at all. Super good boy who listen and obey his mama well and very very very extremely Guai. Today he make me scare. I’m so sad.
10pm+: I’m back and he is fine but I still skip night Subcut. Will give him Subcut once a day then. Given gaba n azodyl. Serve tuna w salmon he got eat w mama. A bit. N a bit of RC urinary pouch.
















22 Sep 2023
7am+: staying on the window sb. When mama approach him can see that he will be happy n meet up w mama. Serve food he is keen but not eating. Syringe him 27ml of ad, can swallow la.
2pm: Subcut him and given him all meds. Serve tuna w chicken w aixia oldie – still not eating.
10pm+: i didn’t see him when I enter, I’m scare. He is in the cat condo box and i Subcut him n given gaba. serve food and he is happy w mama again, keen on food but didn’t eat again. tmr morning I got to syringe feed him b4 i go work again.




21 Sep 2023
5/6am: I don’t know is don or jumbo meowing. jumbo did meow when I open door a few times cos he wanna come out roam. Don in pain? Scare? Stress? Want mama?
They got very early breakfast.
Don didn’t eat. Given Subcut w kcl, bupre, gaba and Clav.
his bladder full? I Duno. Sigh. Means even today iv is off, I’ll let him stay in one room by himself first cos I need to monitor he did pee.
Sigh he keep meowing till I got to scold him, smack2 butt n told him cant make any more noise we will get complains. put him and mama in room a while we wait for 10+ can go clinic take out iv cath n Take bloods.
7.27am: I’m dead tired but can’t sleep le
1220pm: seen dr Brandon who didn’t even want to go into consult, want go to the back for blood drawing n iv cath. end up cos I must be ard, so draw blood from jacular (a lot like >2ml?) and iv cath removal (don v Guai). Then I ask for the checking of bladder whether full, then checked ok not. Then that’s it? didn’t do consult?? Didn’t do other check? Sigh
5.05kg – gain 320g in 1 week
Temp 38.3 – I ask dr take his temp when his results r out, but he got listen to him (should be nothing significant) b4 taking temp.
His results r out: HCT 16.9%, have to start darbepoetin 0.12ml based on 20ug. I’ll start fercosang, b12 b com also. darbo will work cos his retic not high enough. Start Marbo also cos his wbc still high w Clav, Marbo 2% 0.5ml. So I give 0.1ml 10%. Potassium back to 4.5%, I can wean down after finishing his current bags. Kidney still cui sdma 23, but anemic more urgent I reject continuing iv.
Bring him back 猫房 to be w mama. I go 5G fetch med. on cab he looks so much more
Comfy and happy. I got to Subcut him day and night I think so Xiami shall do it twice also.
Dr Brandon says review in 1 week or earlier if he got breathing issue due to anemic. Erm sound scary. But I’ll bring him later than 1 week cos I need those new med to kick in.
Given sc, b 12 b com, fersobang, darbepoetin, bupre, Marbo. starTed him on azodyl also, twice a day. And continue cystaid.
Night: he looks better, lying at the window sb. Subcut for the third time. Told him tmr onwards is twice and he knew it cos it’s without iv. Serve food but he didn’t eat. It’s an issue.








20 Sep 2023
Morning: no poo, got pee, this bandage is not off so good, but the iv stuck and I need to flush his vein. I think it’s not good Tmr confirm must change. given bupre.
130pm: given gaba and Clav.
2pm+: Message from Dr Nally “No difference to treatment plan, review as per our previous discussion. As for Don, its due to kidney injury hence not eating after unblock (fpli is normal)” – his is 2.1. So his is not pancreatitis- I will skip tonight bupre. I’ll give once a day only and will down to 0.15ml. drip rate remain 25ml/h w kcl.
serve food didn’t really eat.
Night: flush and can’t. The vein poke le. He is without iv since 4.30pm. msg clinic Tmr we going check Chem10,sdma and lytes. I most prob stop his iv. Unless the sdma is worse off. Or >20. he confirm much happier w mama. He did meow at me tonight.


19 Sep 2023
Morning; no poo. Got eat. Got pee.
Serve food eat lesser, think swollen paw in pain. May need to go for Rebandage earlier than Fri. he took out the pressure bandage I put last night. I wrap a smaller one again.
Given third Cerenia iv, will stop.
bupre still twice a day w extra gaba.
6h off iv.
1030pm: did finish food. Want food but I serve n yet he didn’t really touch. Like quail egg, added to his kibble bowl. Drink lots of water. continue w new dripbag w kcl. This bag will last till wed 6.30pm. Just nice b4 I go out will off at 4pm. still looks in pain, today got bleed from cath when I flush the port.
paw bandage out again n swollen and I Rebandage again.


18 Sep 2023
6am+: I’m worried about Don. Can’t sleep. Lucky got eat. Serve food tuna w white fish and RC urinary – not keen at all. Look in pain. Eyes not ok. given gaba, clav and bupre. Iv continue. I need him off iv on wed if Thur he wanna bath. he needs to bath.
Syringe him 20ml of aixia oldie cos I serve n he also didn’t touch. Carry mama go see him. He is happy to see mama. N smell mama.
1052am; back to bring don to clinic. Full. So I let Alex do the check on the leftover stitches, and the change of iv cath. Take Cbc n lytes to make sure basic is okay. Alex says is very good boy, he can do check (stitches I cut but one stuck, just pull out only) and change iv cath and draw blood alone. Will see dr Nally next wed. This Fri i recheck Iv again. This Thurs grooming cancelled cos confirm need don to bath after iv take out.
Cbc: HCT 27.2%, drop Liao. Expected but ok la. Later I go back will give him a b12 bcom jab (sc to protect iv line).
K is 3.0 – I’ll add on kcl to the current 700ml bag. Next bag will put 2 vial.
Sigh I didn’t see dr cos they bz, since I take bloods n I go back. Just cos she give me the bloods n she told me the bloods n consult charged, don’t make sense. I can’t accept things that don’t make sense. I just want to see his anemic status and his k level. That’s all. Noted that for bupre to be dispensed need consult. But I didn’t need it urgently, so the whole thing still don’t make sense. I can just top up next wed when Don see vet for full check. Erm. Don’t make sense, I’ll rethink. Most prob I might cancel wed appt then.
1pm I’m back from vet. flush his iv and start him on iv at 25ml/h still w kcl added. given b12 n bcom jabs. I know he want to be cageless. Let’s aim for next wed if grooming confirm on Thur.
2pm: don look ok.
4.30pm: looks better. Given gaba. Told him I going to work soon. serve tuna w Chx ham, he got eat 🙂 so is K too low. Iv stop from 4.30-9pm, 4.5h. I’ll restart when I’m back.
930pm then restart iv. Food cleared. But serve new food his reaction aren’t as good cos his new iv front paw swollen. Pressure bandage for him. Today he poo more







17 Sep 2023
7am+: looks sianz, have to check later on whether he got pee on his own. Got some poo, Got stain on the iv line, given bupre iv.
His poo are formed, 2cm x 2 PCs. clean his butt. Given him Clav and gaba. Say sorry to him for yesterday removing of stitches. he did pee on his own alr. iv stay. I still thinking Tmr or Tues go change. If purely change then maybe Tmr. Then I don’t take bloods. didn’t eat. But I think he did touch kibble. Water bowl confirm got touch. His cool collar damn wet, I change for him to a S size one.
Night. Food not touched, water bowl a lot gone. He looks v uncomfortable. Alr on twice gaba n twice bupre daily alr. Even w Clav n Cerenia. Erm ??
Restart dripline fr 7.30pm. Left max 10h, so I got to change drip line tonight. Think Tmr go check cath safer.
Serve food got eat a little only (3%)
11pm: food all wet not touched. He looks v unwell. Think Tmr need bloods. I change new iv bag. Sayang him and serve him a new plate of tuna w chicken ham. And quail egg. He is keen on quail egg. But don’t seem to be able to eat much. Not sure if his kuku got issue or not


16 Sep 2023
Status: Thu he on iv for 2.5h, then stop 5.5h then continue 18h then stop 5.5h then continue 11h then stop 5h. I will restart him later at 230pm when I reach home.
this morning he got calling sound. Something wrong? Still pain? Given bupre and Clav and gaba.
220pm: restart his iv. given gaba. serve food did eat a bit.
340pm: did try to cut off the stitches. – can’t. He of cos move plus it’s dark plus I’m not used to their private part, so play safe don’t anyhow do. Go clinic then cut off. Maybe Mon go check iv cath n cut urine cath.
Asked Sunny to help ask dr nally on “Today is Don third day on urine cath. Any consequences of removing the cath only on Tues aka day 06?” – “if Don’s urine is clear, he is not vocalising or in discomfort can remove u-cath herself. and yes cos u-cath left too long worsen any infection and causes irritation to urethral lining” – Erm I go back and attached light on my head and die die try again. Cut and pull out. Left one stitch on his skin, tue then let them cut away. clean his private parts w f10.
He did vocal. I throw all pads so I can monitor if he pee on his own.
8pm+: serve tuna w white fish and dd sasami. He got eat. given Cerenia and bupre. Continue iv at 25ml/h thru out.
Today is 230pm till Tmr 8.30am I got to stop his drip and this round for much longer hours, cos I got Cc n I got to feed the 5G cats then rush back home Tmr fastest is 7pm, so is 10.5h w/o drip. Erm maybe Mon go vet better. Check caths but not blood.








15 Sep 2023
7am; auto awake cos worried about Don. I can’t imagine I got to show kerry Don body or something. He is alive. Eyes show me he is in pain. and hungry for sure (didn’t eat, think cos of the stupid collar). Remove for him n change to cool collar and sayang him. He knows he is a cat w ah mao, w his mummy n big bros. serve tuna w salmon, nit a little only. Better than nothing. serve w quail egg also.
Thrown one full unicharm Peepad. The rest stain w the aixia oldie that I serve yesterday.
Given 0.36ml bupre.
Carry mama up to see him.
Today will start him on Clav. Yesterday forgot
Today 5-1030pm 5h off iv, clav given. he did eat. 🙂 this bag will end Sunday.
Bupre given.





11 Sep 2023
1+; status I think I need to know his kidney status now.
Don 12.9.23 Tue
9Am; he didn’t eat and look unwell. Sigh think I didn’t manage to bring his kidney back to normal. or maybe he now felv le?
Night: i bringing him to vet this Thur. Details sent to clinic:
🦊 Don review
Kidney. He got something wrong these few days. Either kidney worsen, or Gana felv alr. So unknown.to retest idexx fiv felv.
V weird keep meowing. Even at this timing 1141pm. In pain? Or felv activated? Alley first become felv also like this. I think he maybe also pancreatitis? Felv? Sigh. He got drink water on his own n don’t eat when I serve nice food. I think kidney worsen maybe also. Sigh need factual info
He is currently on:
1. Subcut on off
2. B12 b com
Today and night I give him gabapentin 45mg cos of the meowing I get scolding.
Don tonight a little scary, sitting w mama, mama like consoling him. Cardboard is wet, his butt is wet, Tmr think he needs to take urine also. He got something more wrong. Saw him drinking water also. Kidney much cui?
Don 14.9.23 Thu
4.75kg – lose 550g in 2.5 months
First thing to spot: cos his body and below body and belly are wet – he is blocked. Bladder big. Methadone given to calm him down n let him don’t be so pain. need sedation to unblock him and see how.
1115am: alr 45 mins Don is in cage to get ready. me and Xiami and mama waiting.
He is to take Cbc, chem15, lytes, sdma, pancreatitis, Fiv felv.
Dr nally says blockage mainly due to stress. But only stress i can think of is his mama sick then he stress but mama is quite ok. So I still think is he sick till he stress.
1209pm: anyway he under sedation starting unblocking now. dr will let me bring him back w e collar, and urine cath intact. I’ll remove his stitches (4) on sat on my own. have to cage him these 3 days.
To start him on ab Clav, 0.24ml.
Sdma 25, kidney might still be acute. Phos 10.6 but due to current situation see first, fluid might let his phos go down naturally. GGT 5, also same due to current situation see first. k is 2.9, low better than high, so safer to go thru ga. I won’t anyhow add potassium. Will see how. Sure need review bloods to see status.
12.14pm: we still waiting for Don. The nurse says might be 2h, fastest is 1h.
1220pm: Don is awake. cath is in. Review Mon / Tues. I can take out if I think he is fine.
then he to continue iv, at 25ml/h day 15ml/h night.
He is still felv negative. Fiv positive.
Treatment plan: iv, Clav, bupre, gaba esp. cystaid will help. I’ll give.
Confirm no crystal no stone
Also pancreatitis abnormal. also sending out spec – so he on iv also just nice sure need to give Buprenophine iv.
4+pm: given cystaid. No reply from clinic on what one onwards I can give bupre after methadone. So didn’t give yet.
Serve ciao he did try to eat but didn’t. I’ll see how first. Tmr I will change to cool collar for him.
4.28pm: told him in case iv machine beep while I’m at work so better I off it. Tonight confinue at 25ml/h. Stop at 4.28pm 62ml done. Tonight continue (438ml) – can last till Tmr 4pm. Just now b4 I go lessons I will change to 1000ml bag.
Methadone bupre 6h apart so tonight I go back I give him.
10.35pm: restart iv at 25ml/h. I got flush the line. he isn’t looking better than this morning. Didn’t eat. Think also hard to eat. Tmr day time I’ll have more time w them, so I’ll take off his e collar n change to cool collar.
Given bupre.











03 Sep 2023
7am: food overnight w KitKat chicken – a lot of food left in the room.
Don 5.9.23 Tues
Noon: Given Subcut. B12


24 Aug 2023


22 Aug 2023

18 Aug 2023
Night; Don love ciao cup like alley?
Oh is ciao cup under aixia? Going to raise price from 1.9.23? Wellness also mah omg


17 Aug 2023
Night/ midnight: I can’t be sure but I think is either alley or Don keep meowing. moved to big room but keep meowing. I got to shut all windows

15 Aug 2023
10am: shifted them to Totoro room for holding till air is better. We repainting room today (lousy job done)
Their spot r tgt in the big box. Stick tgt. Told kerry her nose like that so all the more they need to be here, if Thurs or so I bring alley they all back, kerry and Don most prob stay here longer cos of the smell.
5+pm: Serve ciao cup as snack – happy got eat

08 Aug 2023
Noon: tried to Subcut him n only a bit, cos kerry pull the needle out




26 Jul 2023
10pm: serve tuna w salmon n dd sasami he like
Don 1.8.23 Tues
430pm: start grooming. Can only cut nails n clean ears cos not enough time. he shiver like mad loh.
Don 2.8.23 wed
Just a log that this boy Subcut drip always flow v slow



24 Jul 2023

18 Jul 2023
Noon: given Subcut and b12 b com jab.




14 Jul 2023
1am: fighting sound. I didn’t dare go on light. Go in and chase alley out of room d and shut room d w kerry n Don in there
06 Jul 2023
3pm: teabreak b4 I go to work, everyone eat except daring – tuna goji berry.
Sigh skip Clav tonight cos not enough.
Don 7.7.23 Fri
Today I brought Clav back to 5G le. Will continue Clav jabs


05 Jul 2023
Morning: everyone got eat breakfast except mama who jump into the bath tub after Don Don come out. When I first walk in, Don is inside resting

04 Jul 2023
Morning: Today given Subcut, b12 b com jab.
This boy easily scare, cap drop he freak out.


30 Jun 2023
Backlog msg fr dr nally 28.6 wed: “Rv in 2wks for rpt full UA/renal panel, kiv urine C&S (O declined today). Start clav inj for 14days.” – ending on 10.7.




24 Jun 2023
850am: sayang them direct today. All 5 come sayang tgt. Then I clear poo, wash bowls then serve food. Got eat. Kerry and Don still loving. Don stick ard mainly cos of mama ard
Tonight supper serve kc tuna classic and tuna w white fish n selar – all got eat. 🙂
Don 26.6.23 Mon
1030am: I look at Don, his face sunk in. He looks so much thinner. Sigh. Have to check. I’ll Subcut him more this week n go vet next week
12am: 5.28kg – lose 360g in 1.5month, going to see dr nally Tmr. serve RC instinctive and tuna w white fish, got eat. Subcut him w b12 b com
Don 27.6.23 Tues
Morning: Subcut him.
5.54kg – w Subcut. taken renal profile and UA.
Urine sg 1.009 – got protein n glu, then no bacteria seen. But there is a common crystal in both Don n Xiami. Dr nally wants to send out culture n sensitivity – suspect secondary UTI. I reject avd test. Will just whack 14 days ab Clav 0.28 then review. She says if they still find crystal then, she will want to send out the avd test. Crea bun not ok. But sdma ok. Erm.
1048pm: I draw and bring back Clav fr 5G to 4G for Don. tonight start him w 0.28ml Clav jab. Jab ending 10.7.23.
11pm: given Clav jab, he is a good boy. He so handsome that nurse Amanda and vet Dr nally like him.
bcos Don needs, since suspect UTI, I serve sparkles tuna crab w RC vet urinary pouch – don got eat
Don 28.6.23 wed
Night: eating seem ok. Clav jab.












19 Jun 2023
9Am: serve tuna w chicken ham and kakato salmon in broth – got eat.
Night: I’m still considering about Thurs vet visit. I most prob will cancel for all. Don aren’t that necessary. Tmr will Subcut him when major cleaning
Don 20.6.23 Tues
Noon: Subcut w b12 b com
650pm: given Instinctive snack


28 May 2023
Night: Subcut him.
Don 5.6.23 Mon
Sacc stock is here, so started them w sacc here onwards.








23 May 2023
Night: Subcut him. Told him have to recover want to be w mama long2 he is a good boy
Don 25.5.23 Thurs
Day: bought them a cycle wheel. Didn’t see Don on it yet.
Don is cooperative when i Subcut him.
Night: got diarhhoea in bin Duno who, given probiotics
Don 27.5.23 sat
When I Subcut Xiami, Don is looking, told him that’s why quickly stablise his kidney if not like Xiami alr chronic will be more troublesome next time. He is good boy cos he know I do everything for him to be w mama long2.





18 May 2023
Subcut w b12 b com



12 May 2023
Bring him see dr Brandon.
5.xx kg – forgotten but I think drop a lot again.
Told dr he started after mama start to have nose issue, he stress? Till fur drop also.
Wanted to test him for pro bnp but clinic only got vcheck so didn’t test. Cos he so stress when taking bloods, he vibrate shivering like hp vibrations like that. Scary.
“Don showing signs of kidney disease Crea 2.6, BUN 45, FIV +ve, FELV -ve. Can start SC fluids 100ml hartmann’s /day. Maybe 1 month for Don just to make sure the values have gone down” – I log in 5 weeks later.
In trolley carrier Kerry stack on top of Don, but she still groom Don Kia n Don ok as long as w mama. I’m so worried what if mummy is gone … Erm he didn’t get felv yet.
Later will Subcut him b4 I go to work.
11.30pm Subcut him. Not as scare as in clinic, but towards the end he flip over like Kerry and he like scare of the after feel of the fluid bag.







11 May 2023
925am: fr Ip mama grooming Don Kia

08 May 2023
Morning: 5.xx kg – my brain too tired, can’t think. I know lose a little weight. Lucky not that bad. Given him 1.5 drontal. this Fri will do checking




07 May 2023
12.11-12.23pm: Don play w cockroach.
Wa 12.23pm he hit the vacuum uncle and it’s on till I rush back at 5+pm to off it. They so scare loh when I back. Quickly give alley a tight hug, and daring keep grooming Xiami. Kerry come sayang also. All eat ciao cup.

23 Apr 2023
Fur aren’t that nice. Dry dry.
Don 24.4.23 Mon
Night: I see he like thinner a lot. Got problem leh. Kana felv le?
Don 25.4.23 Tues
Morning: daring enter his room and groom him. He gonna live w them so Erm. got daring sayang also. he still look lively, and lovely w mama.
Don 29.4.23 sat
I didn’t see him eat leh. Always laze ard
Don 1.5.23 Mon
7am: ever since grooming fur losing leh. Stress? Allergy to revo plus?
Don 2.5.23 Tues
Morning: I sayang Kerry and feel her felv seem to be acting up and she might have nose cancer now? I might bring her n Don for a check these days for Current status.
13 Apr 2023
8.13pm; checking ip on cute and saw Kerry and Don sitting stick tgt, v cute

09 Apr 2023
7am: overnight didn’t clear much food
Don 11.4.23 Tues
310pm: Don first to groom. He run and crawl up the netting, he injure 2-3 of his nails. Bath quite stead. Drying keep wanting to run away.
5.64kg – lose 280g. right eye ball also got issue, something.
Revo plus him.





















08 Apr 2023




02 Apr 2023
650am: Don and Kerry didn’t eat anything overnight … Erm
Don 5.4.23 wed
Night: celebrate his 7th 猫房 bday.













31 Mar 2023



29 Mar 2023

28 Mar 2023


19 Mar 2023
1+pm: 5.92kg – lose 520g in 3 months. Kiv. Still look loving w mama. Though I seldom see him eat.


24 Feb 2023
Night: left side eye a little issue, but I clean n check nothing. Kiv. Generally i feel n thought n observe Don don’t eat much. But his size still looks good leh. Did he get felv alr?



18 Feb 2023








16 Feb 2023


31 Jan 2023




28 Jan 2023
Morning: all good kids, they somehow know why they r trapped in room D tgt cos ah hei funeral going on. They didn’t give me problem. Both still loving to each other









27 Jan 2023
Bcos I help ah hei w funeral, today special, full aircon and I let all 5 of them stay in room d. Somehow they know la. each mind their own biz. Kerry and Don are fine.
Night: they eat tgt on the multi layers shelving.
21 Jan 2023




19 Jan 2023

17 Jan 2023
4-730pm: supposed to cut nails and clean ears day only – end up everyone get to bath. Don is the first, my left hand got a cut cos he scare and jump on me. nails super long and sharp. Pant a lot while he observe alley daring Xiami back from bathing and drying.
He not ok but didn’t go bonkers w dryer la.























03 Jan 2023

30 Dec 2022



29 Dec 2022




27 Dec 2022






26 Dec 2022





23 Dec 2022


21 Dec 2022

17 Dec 2022
645pm: 6.44kg – gain 250g in 4 months. No neck to scruff loh.
when nights out, I put Kerry and Don tgt in room c prevent fights.


06 Dec 2022
1105am: fighting – should be Daring and Don.
Don 10.12.22 sat
Damn handsome, like the new Cattree I put in room c for him n mummy.








29 Nov 2022
430pm: rain finally stop i quickly got to rush to bring char to 5G. hug her tightly to see kerry mama and don bro as rare to be able to see them in person. Think Kerry know … Don dote on his sister one but he Duno how to react so he hide
11pm: Don is calling – calling Charmander? I open door told him char go Jack papa side alr








26 Nov 2022


20 Nov 2022
635am: awake cos of meowing – later I found out is Don cos he wanna pee. He and Kerry in room c w the blue bin w Peepad – ha he don’t know can use that, good kids they are.
Don 21.11.22 Mon
625pm: I’m super rush alr, but saw his left eye got issue, clean up a little – swollen a little like Xiami normally. Tonight then halid him. Q him w mama in room c – at night I reach home then check again.
1130pm: checked – not that bad. Clean up and halid. Q him n mummy in room overnight
Don 22.11.22 Tues
1040am: eye didn’t worsen, eating as usual
240pm: clean up eye, put halid
Don 23.11.22 wed
His eyes r clear alr



05 Nov 2022
5+am: woke me up, able to fight le, or maybe alr fight. Sigh. Alley vs Don. Don wanna be felv- also hard le. But that’s the choice I make, he is happy w his mummy. Mama better be 长命百岁。
Don 17.11.22 Thurs
5pm: do I start to feel that Don might have got felv le?
Don 18.11.22 Fri
Night: tonight: tuna w crab meat w RC indoor pouch – got eat

13 Oct 2022
01 Oct 2022
22 Sep 2022
13 Sep 2022
06 Sep 2022
04 Sep 2022
27 Aug 2022

Morning: don’t know is which of the 4, alley, daring, Don or Kerry – like to pee onto the nice round sb. So wasteful. Room d got pee stain have to keep mopping. thrown away a few alr. This last one might need to throw on Tuesday latest during major cleaning round
Don 29.8.22 Mon
night: generally quiet, w mama or alone in room d.
Don 31.8.22 wed
Night: still generally quiet
19 Aug 2022






Night: given tuna w chicken w dehydrated sardine. Got eat but im worry about the Sardine bone
Don 20.8.22 sat
Morning: given breakfast tuna w salmon w dehydrated sardine (I’m worrying more cos of lots of bones) – don’t seem to like the fish anymore. end up I got to open extra bistro chicken for daring, Kerry and Don.
Night: given them the the chicken fillet treat agnes give Kerry Don, all happy w dinner 🙂
08 Aug 2022
06 Aug 2022







Night: i merging Totoro w them n give them the whole q room – so by right more comfy more place to run and stretch n I can sit down to sayang them also. But i a bit worried that Totoro Might infect Don more? Will? Sigh.
Don 7.8.22 sun
5pm: Totoro is in room c while I’m preparing T room to shift Rena n princess over. Kerry and Don r curious about Totoro.
6pm open up room, merge w Totoro. Kerry did come out a while, don stay put in room D, while Totoro causing harvo (eat here n there, eat until super messy). Serve ciao cup – think they overwhelmed didn’t get to eat.
840pm: i re-enter for night round, somehow this gang still eat in room D. Kerry and don not much changes.
930pm: fr ip not sure is k or don in the 3 ways tunnel.
17 Jul 2022
05 Jul 2022
29 Jun 2022






7.40am: Don very hungry like that
Don 30.6.22 Thurs
Teabreak: we have kakato chicken fillet- they like
Supper: Don and Kerry sitting tgt v cute I don’t have my phone w me
Don 1.7.22 Fri
1am: why don’t know why alley and Don is “fighting” w their meow… alley look like the tame one. Don looks aggressive. I only ooi them once and dispense and alley is tamed and just sit to rest so it’s peaceful.
Don 2.7.22 sat
Really like the sb, will rest on it
23 Jun 2022
31 May 2022







10pm: Don should be a happy boy tonight, he happy boy since i merge him to Mama room, Tonight Kerry mama groom him too!!!! Don Don is the happiest kid in the world!
Don 1.6.22 wed
706am: I woke up got some time cos Don is meowing. Omg. he is at the top of the play deck.
920pm: on ip, Don and mama sticky tgt, looking out but I still got to go 5G first
Don 3.6.22 Fri
Night: Duno why these 2 days Don high up leh, away from mummy again?
Don 6.6.22 Mon
Morning: generally ok. yesterday still got sit w mama on the window platform. got eat for sure.
Night; alley daring bday celebration. A small sb added to the room, Don and Kerry and daring like it.
29 May 2022
28 May 2022
27 May 2022




130pm: brought Don back to mummy side, he is destined to be in felv room – hard decision. I’ll keep him as healthy, but he shall be w his loving mum. Mama didn’t reject when I put him in. He squeeze into the cat box w mama.
Night: he confirm looks so much livelier loh. He got come close to mama but mama beat him up, he still look happier as along as he is w mama.
26 May 2022
22 May 2022



Sayang him again, he is handsome.
Don 23.5.22 Mon
Whole day junior bullied Don at least 3 times. this is the reason why I even consider letting Don get felv but go merge w mama
Don 24.5.22 Tues
Junior bullying Don again, once Kerry move to room d, I think I’ll just test her one more time. Will let Don merge in w her? I can’t make a firm decision yet.
22 May 2022




Still didn’t move fr that spot. Even poo are formed there, means he didn’t even come down to poo? The pee I found the other day near window is his? High chances is. Junior fault? Or simply cos mama not ard? If such case, if he can’t get adopted, I might as well merge him w Ma. When he is alone in room c, he is better off than here. Sigh. I sayang him he also scare, I serve him extra kibble – he got eat. When he scare run away fr me towards sheba, sheba fierce to him
18 May 2022








1010am: bring Don wait for cab. He cry I also cry w him, told him no choice, his mama understand one. I know if u r negative, ur mama would want u to live a good life, can’t be stuck w them in the felv room. i got to be realistic, alley I can’t change the fact for him, logically no reason to infect Don for wanting to merge them.
Don cry he is very stress I know.
11Am: Since we are going to draw blood, told dr Cheryl take all, fiv felv, Cbc, Chem10 w phos.
Dr says he is a good boy, didn’t attack but fast and strong, the moment carrier open he want to dash. Drawn from his left hind.
Dr Cheryl says his weight is 6kg – drop 180g, I didn’t check. But his size looks good. i think she mean he is 6+.
Results out: fiv + felv – (result same) make the sensible decision to split Don w mummy, bringing him to 5G to let him run n play. That’s what mummy would want too, though I know she miss him. I can still bring Don smell back to her.
glu urea still high, but dr Cheryl says stress and didn’t seem to think much about the urea.
Phos is normal, at least i can filter out any kidney issue for now. cbc is good so health status cleared.
1210pm: bring Don back to 猫房 5G, the kids welcome him. Sena also kiss him. Bday boy ah boy kiss him too. Think junior wanna bully Don got scolding by me. He jump back to the same spot behind the cctv at the bridge. let him be.
2pm: fr ip: he is alone up there sleeping.
650pm: fr ip: he is same spot but at least eating
Night: he got eat. but Duno when he will open up.
15 May 2022
14 May 2022
13 May 2022
12 May 2022


Stupid me didn’t think of the man can repair the netting from Rena room, i quarantine Don in the cage since 9Am – he meow a lot.
Nvm la. Also scare he anyhow jump while repairing.
1130pm: alr start meowing, given him a catnip sachet. Think I got to order le. Faint. i go book slot for him to retest recheck then back to ?!
07 May 2022




1130pm he start meowing I check up he standing on the edge at netting, so scare he jump to room d. Go close all windows b4 the sound issue.
1209am: I can sleep everyone Guai. I just now suddenly feel like implementing plan b. But sigh I buy 2 new hanging beds le – but can just sell away la. Erm i think first – Maybe I should trial for the next few days
Don 8.5.22 sun
130am: sigh he meow non stop I got to go in sayang him. I can’t even feel he happy to be sayang or not. But he might be stress? Want mama? Or just v stress Duno what to do alone in the room? the earliest I’ll retest him but I don’t want but no choice cos his meowing will cause a lot of issues – 19.5 3 weeks after he retested. Afterall he is a negative I’m just playing safe to RE RE Test him again. At this rate, Tmr I might need to feed him gabapentin b4 we go to bed.
Given him catnip for tonight he got eat it but meow again I open door told him don’t I need to sleep, I alr work non stop leh.
145am: so far ok. I got to sleep.
245am: again n again. Given 60mg gabapentin.
602am: he is at it again. Anyway he didn’t eat much bistro chicken yesterday. He did eat kibble.
615am: serve white fish, he got eat
10pm: He did eat. Poo 5/10.
give him a pack of gold d catnip sachet he like. I prep 75mg gaba but I didn’t give him.
Serve a big plate of food, sayang him told him I really long time didn’t sleep le like panda le.
Don 9.5.22 Mon
7+am: did I drop dead? Don didn’t wake me up or is he guai2? – good.
I end up wake up early though I can sleep late
515pm: serve snack – gold sardine – he got eat.
04 May 2022





115am: go into room cos he keeps meowing non stop. play w him he got frustrated first time attack me? He got no nails or I’ll injured.
9Am: poo a lot, formed 5/10
Book May 30 Mon 3pm review – that’s the date he will merge back 5G or go join Kerry
1132pm: Don do like the o2 chamber cage, i think Tmr I will clean it up throughly
N put heat pad n let coco sleep in o2 chamber.
Don 5.5.22 Thurs
1130pm: relax position on floor resting. i might need to retest him earlier if he keep meowing randomly during mid night. Got one piece of 2cm poo rather dry.
Don 6.5.22 Fri
5-6am: he look at me cos I fierce stare at them making noises.
9am: given food
1130am: poo formed 5/10
Food intake so so.
Hug him sayang him.
Subcut him just plain fluid. Ok he is quite fine w it, next time then give b12 n b com. Told him next period we will do Subcut n see how and go check one more time he felv negative we will go back to Jack side, his mama would like him to be a healthy boy.
01 May 2022



Don will meow a lot. i sayang him, he got eat both wet and dry. Poo 5/10 nice. I’ll arrange him to retest and body check after 29 may. This period need to remember to Subcut him weekly maybe. See how.
Don 2.5.22 Mon
Today relatively quiet in the morning.
But got eat la.
Counting down the days he and mama won’t see each other anymore
Don 3.5.22 Tues
Morning: got eat, but relatively hidding? Sigh.
like ciao cup too.
Night: got come out for sayang. Food cleared.
Top up his u/c pallet.
1240am: keep calling non stop, asking for mama?
28 Apr 2022




9Am: same position, hiss at me w renny. Still catch him not that difficult – did he slim down cos even the weight like easier.
10am: bring him go retest fiv felv – I Duno why I’m quite worried about his. Maybe cos of the unlucky curse given by nonsense.
Jennifer told me Don need gaba, only manage to test for fiv felv only, not enough to test for Chem10 i think the blood they spin down, Duno how much to trust. Tp 95, glu 13.88 high cos he damn damn stress, crea 250, i think I shall just Subcut him to see how.
Fiv + (I can’t think of why)
Felv – (I can’t think of why too if mummy is positive y he negative???)
I think Don i one month later will retest le. I don’t feel safe putting him to safe room so I bring him to room c, he shall stay alone for one month and can still see mama next door. 1130pm: I remove his bandage from his hind
Didn’t touch food at all.
Don 29.4.22 Fri
9Am: more active than yesterday. Will meow. Echo mama. given food – eaten a little, but he confirm got eat kibble.
Teabreak got eat more.
11pm: got eat, n water bowl is almost empty, sigh didn’t get his Chem10. Next month try to get it when he go retest.
23 Apr 2022


Morning: v happy see Kerry up there w Don. She came down anyway, I think Don scare of junior.
Don 25.4.22 Mon
Night: aiya he is still up there, in view of alley issue, was kind of worried about Don. They like same same like that.
Don 26.4.22 Tues
10am: super happy though I think I should be dead stress n sad n worried cos of alley case now – ha he and mummy confirm sitting tgt on the top deck. Now it seem like Kerry is the one who told Don don’t come down maybe someone bully n she is protecting him?
06 Apr 2022

9pm: back to top deck. Sayang him a bit.
Don 7.4.22 thurs
Morning: still at top deck, change position w amber
Night: rush to feed them and Don is on ratten shelf let me sayang him, majiang they know the good news – tmr see where he is
Don 9.4.22 sat
9am: still at the top of deck, not w mummy. Give him bistro chicken he like.
05 Apr 2022










I think i in a rush n vibes not good. Duno why since last mon grooming, kerry n Don split and Don keep staying up on the high deck. I carry Don down and check his body In case is any injuries but don’t have. Just that he become v stress and negative. I carry mama to Join Don, she whack Don Don leh. So sad. Told them all the more they know they leaving have to be more loving and hug hug kiss kiss w me mah. Give Don a cat nip toy but he end up hissing
Even more stress. He did want to eat the bistro chicken but Oly keep wanting to snatch from
Him.
Don 6.4.22 wed
Morning: I carry Don down again, hug him, bring him to mama, he got lick mum thrice and smell her butt, Kerry whack his face again. He so poor thing looking sad, I sayang him say I also Duno y mama like that now. Told him to stay at Lower deck so mama can see him more often. Still my very good boy who didn’t show any aggression to me.
28 Mar 2022
20 Mar 2022


Kerry and Don PA visit, Kerry know since a few days ago, this morning she is v quiet at one spot. Don I carry him to find mummy he freak out, my shoulder n Stomach few more wounds. Nails sharp but length ok, Monday groomer better don’t cancel on me ah.
At night, they know coast clear, I come in as usual rush rush mode they happy telling me sayang. Mama as usual LLL … Don as usual listen to mama and sticky 2 waiting for me to kiss.
18 Mar 2022
20 Feb 2022

Morning; accidentally close his left front paw into wardrobe – he scream n run away from me. I got to chase after him n sayang lots n say sorry to him then he know is accident
Night: sleeping in basin
14 Feb 2022

07 Feb 2022






31 Jan 2022



19 Jan 2022

Day 03 at 5G, still seem rather scare
Don 20.1.22 thurs
1030pm; generally still inactive at 5G
Don 21.1.22 fri
Night: stress? He is the meowing
Don 26.1.22 wed
10am: heard Don sneeze 1 time
17 Jan 2022
11Am; we moving to 猫房 5G. 6.12kg – gain 680g. Scare, keep staying in one of the cat
Box shelf. near mummy, but not together. panting.
Don 18.1.22 tues
1015am: still scare but Got sayang. Got come down meet mama cos mama meow3.
Afternoon: #猫房kerry and #猫房don day 2 at new place – alr sticky mummy son pair 🙂
29 Nov 2021
30 Oct 2021
24 Oct 2021
23 Oct 2021
11 Oct 2021
19 Sep 2021
11 Sep 2021
25 Aug 2021
Afternoon: checked: his leg is fine, can walk not lift up alr, not limping anymore so is the nails. Omg y his nails grow so fast – he n mama had grooming the other time.
Don 26.8.21 thurs
Afternoon: checked: his leg is fine, can walk not lift up alr, not limping anymore so is the nails. Omg y his nails grow so fast – he n mama had grooming the other time.
24 Aug 2021
27 May 2021
10am; still loving w mama. I serve tuna w salmon, cover up like poo Loh. I serve w bistro chicken he eat.
05 May 2021
08 Mar 2021
10 Feb 2021
02 Feb 2021
28 Jan 2021
24 Jan 2021
26 Feb 2025


17 Feb 2025




03 Feb 2025






16 Jan 2025










13 Jan 2025

12 Dec 2024



06 Oct 2024



19 Jun 2024





25 May 2024



25 Jan 2024

18 Jan 2024

04 Jan 2024







02 Nov 2023




21 Sep 2023


20 Sep 2023

18 Sep 2023


14 Sep 2023








27 Jun 2023


12 May 2023

